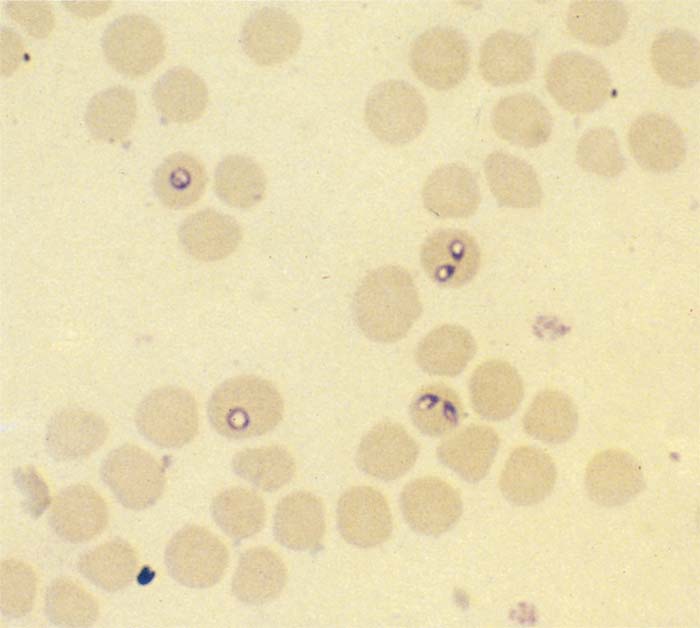
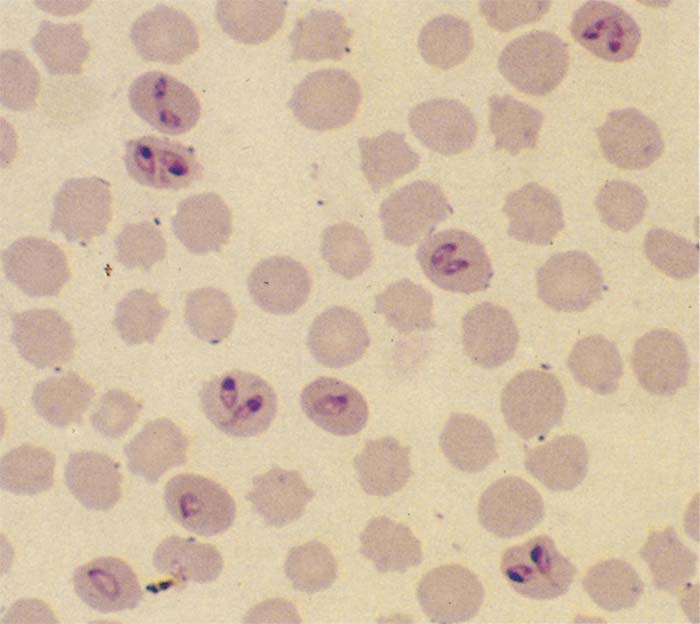

- Infectious Diseases of Livestock
- Part 1
- Bovine babesiosis
- Vectors: Ticks
- Vectors: Tsetse flies
- Vectors: Muscidae
- Vectors: Tabanidae
- Vectors: Culicoides spp.
- Vectors: Mosquitoes
- Classification, epidemiology and control of arthropod-borne viruses
- Special factors affecting the control of livestock diseases in sub-Saharan Africa
- The control of infectious diseases of livestock: Making appropriate decisions in different epidemiological and socioeconomic conditions
- Infectious diseases of animals in sub-Saharan Africa: The wildlife⁄livestock interface
- Vaccination: An approach to the control of infectious diseases
- African animal trypanosomoses
- Dourine
- Trichomonosis
- Amoebic infections
- GENERAL INTRODUCTION: COCCIDIA
- Coccidiosis
- Cryptosporidiosis
- Toxoplasmosis
- Besnoitiosis
- Sarcocystosis
- Balantidiosis
- Leishmaniosis
- Neosporosis
- Equine protozoal myeloencephalitis
- GENERAL INTRODUCTION: BABESIOSES
- Bovine babesiosis
- Equine piroplasmosis
- Porcine babesiosis
- Ovine babesiosis
- GENERAL INTRODUCTION: THEILERIOSES OF CATTLE
- East Coast fever
- Corridor disease
- Zimbabwe theileriosis
- Turning sickness
- Theileria taurotragi infection
- Theileria mutans infection
- Theileria annulata theileriosis
- Theileriosis of sheep and goats
- Theileria buffeli⁄orientalis infection
- Non-pathogenic Theileria species in cattle
- GENERAL INTRODUCTION: RICKETTSIAL, CHLAMYDIAL AND HAEMOTROPIC MYCOPLASMAL DISEASES
- Heartwater
- Lesser known rickettsial infections in animals and humans
- Chlamydiosis
- Q fever
- Eperythrozoonosis
- Bovine Haemobartonellosis
- Potomac horse fever
- GENERAL INTRODUCTION: ANAPLASMOSES
- Bovine anaplasmosis
- Ovine and caprine anaplasmosis
Bovine babesiosis
This content is distributed under the following licence: Attribution-NonCommercial CC BY-NC
View Creative Commons Licence details here

Bovine babesiosis
Previous Authors: A J DE VOS, D T DE WAAL AND L A JACKSON
Current Authors:
P J ROLLS - Principal Veterinary Officer, BVSc, MVS, Tick Fever Center, 280 Grindle Road, Wacol, Queensland, 4076, Australia
P D CARTER - Principal Veterinary Officer, BVSc, MVS, Tick Fever Center, 280 Grindle Road, Wacol, Queensland, 4076, Australia
Introduction
Bovine babesiosis, or redwater as it is commonly known, is a tick-borne disease caused by the intra-erythrocytic protozoan parasite Babesia. A number of species are known to infect cattle: Babesia bovis,57, 65 B. bigemina,57, 65 B. divergens,193 B. occultans,88 B. major and B. ovata .117 They are widespread in tropical and subtropical areas, and are transmitted principally by ixodid Rhipicephalus (Boophilus) spp. ticks.10 Of these species, only Babesia bovis and Babesia bigemina are economically important63 and therefore this chapter will focus on these two species. Babesia divergens occurs in Europe and is of zoonotic importance.193 Characterisation of less important species, the tick vectors of some species and epidemiological significance are not always certain.75, 77, 65, 178 Babesia orientalis occurs in water buffalo (Bubalus bubalis),90 but is not further considered here.
The acute disease is characterized by haemolysis, circulatory disorders in the case of Babesia bovis, and death may follow in some instances. Bos taurus breeds of cattle are particularly susceptible although the disease can also be economically important in Sanga and Bos indicus breeds. Clinically inapparent infections commonly occur in young animals, and recovered animals become latent carriers for variable periods. Recovery is followed by a lasting immunity to the infecting parasite. Cross-immunity between the two organisms is limited.
Babesia bovis was first reported in southern Africa in 1941141 although clinical evidence of its presence in South Africa was recorded as early as 1905.157 It was probably introduced with the Asian blue tick Rhipicephalus (Boophilus) microplus during the latter part of the nineteenth century (see Vectors: Ticks). Reports from Australia, Argentina and USA are also found in the late nineteenth and early twentieth century.16
Babesia bigemina is principally transmitted by R.(B.) microplus and by the common, indigenous African blue tick R. (B.) decoloratus. Babesia bigemina would therefore have been endemic in the subcontinent for centuries. Indeed, babesiosis is said to have been the cause of high cattle mortality in the present-day KwaZulu-Natal Province of South Africa prior to European settlement in the 1830s.65
Several accounts have been published of the history of babesiosis and other tick-borne diseases in southern Africa and Australia, as well as of the people involved in the early battles against these diseases, and the impact on livestock industries. These reports are well worth reading.7, 91, 112, 170, 172, 181
The impact of babesiosis in Africa in the early twentieth century was masked by a devastating East Coast fever epidemic (see East Coast fever). The campaign to control this epidemic by intensive regulatory control of the vector Rhipicephalus appendiculatus lasted half a century and had a big effect on the single-host Rhipicephalus (Boophilus) spp.., ensuring that babesiosis remained of secondary importance for many decades.
In the latter part of the twentieth century, relaxation or breakdown of tick control measures and the advent of acaricide resistance in Rhipicephalus (Boophilus) spp. caused babesiosis to increase in prevalence and significance to the point where it became recognized as one of the most important livestock diseases in southern Africa.13, 57, 65, 67, 113, 143 (see Vectors: Ticks).
Although the diseases caused by Babesia bovis and Babesia bigemina are clinically very similar, it is important to separate them for a number of reasons. The names Asiatic (European) and African redwater, respectively, have come into common use in Africa. While Babesia bovis is the more virulent of the two parasites, Babesia bigemina is probably more important in southern Africa because of its wide distribution. In this review, however, we pay more attention to Babesia bovis, mainly because it has been studied more intensively, is much better understood than Babesia bigemina and is generally more important throughout the world.
Aetiology and life cycle
The genus Babesia belongs to the phylum Apicomplexa, class Sporozoasida, order Eucoccidiorida, suborder Piroplasmorina and family Babesiidae.6, 114, 115 The Babesia spp. known to infect cattle, and their principal vectors and distribution, are listed in Table 1.
Table 1 Bovine Babesia spp. and their vectors (based on 16).
| BABESIA spp. | VECTORS | DISTRIBUTION | REFERENCES |
| Babesia bovis | Rhipicephalus (Boophilus) microplus; including R.(B.) australis | Africa (limited), Asia, Australia, Central and South America, southern Europe | 16, 77, 157 |
|
| Rhipicephalus (Boophilus) annulatus | Africa (limited), southern former USSR, Near and Middle East, Central and South America (limited) | 16, 73, 77 |
|
| Rhipicephalus (Boophilus) geigyi * | West Africa | 77 |
| Babesia bigemina | Rhipicephalus (Boophilus) decoloratus | Sub-Saharan Africa | 142, 154, 157 |
| Rhipicephalus (Boophilus) microplus; including R.(B.) australis | As for Babesia bovis | As for Babesia bovis | |
|
| Rhipicephalus (Boophilus) annulatus | As for Babesia bovis | As for Babesia bovis |
| Rhipicephalus (Boophilus) geigyi * | West Africa | 77 | |
|
| Rhipicephalus evertsi * | Sub-Saharan Africa | 22, 33, 77 |
| Babesia divergens | Ixodes ricinus | Europe | 193 |
| Babesia occultans | Hyalomma marginatum rufipes | Africa, Turkey * | 2, 88 |
| Babesia major | Haemophysalis punctata | Europe, North Africa, Asia | 16, 117 |
| Babesia ovata | Haemophysalis longicornis | Eastern Asia | 16, 88 |
* Note that characterisation of some species, pathogen-vector relationships and epidemiological significance are not always well-defined and some potential relationships are omitted.2, 77
Babesia bovis is classically known as a ‘small’ Babesia measuring up to 2 μm in diameter, while B. bigemina is larger and can extend to the full diameter of an erythrocyte.153 However, the two species both show considerable morphological variation, making it difficult to distinguish one from the other.37 Large forms of Babesia bovis are quite common.37, 153
Single Babesia bovis organisms are round, oval or irregular in shape while paired forms are piriform or club-shaped. The angle between the paired organisms is often, but not invariably, obtuse (Figure 1).96, 153
Single forms of Babesia bigemina are elongated or amoeboid in shape and contain fine cytoplasmic filaments. Paired forms are typically piriform with an acute angle between the merozoites (Figure 2).96, 153
Babesia bovis is transmitted by R. (B.) microplus throughout much of its worldwide distribution, although these ticks present in Australia and some areas of south-east Asia have recently been reclassified as R. (B.) australis.73 In some areas, however, other vectors such as R. (B.) annulatus may be more important.16 Transmission is transovarial, with engorging adult ticks ingesting the parasites and the larval ticks of the next generation transmitting the infection to the host77, 153 (Figure 3). Ensuing stages are not infected.
Confirmed vectors of Babesia bigemina include R. (B.) microplus (includes R. (B.) australis),33 R. (B.) decoloratus,153, 154 R. (B.) annulatus 33 and Rhipicephalus evertsi evertsi33 (Table 1).
Transmission by Rhipicephalus (Boophilus) spp. is transovarial, with engorging adult ticks becoming infected in the same way as B. bovis, but in this instance the infection is transmitted to cattle by the nymphal and adult stages of the next generation (Figure 3). There is some evidence of vertical transmission in the tick, with infection passing from one tick generation to the next in the absence of reinfection.89, 153 In addition, wandering male Rhipicephalus (Boophilus) are known to migrate to uninfested cattle129 and may play a part in the transmission of Babesia bigemina.50 Transmission by R. e. evertsi is transovarial, and only the nymphal stage infects the bovine host.33
Extracts of infected ticks have been used to infect cattle experimentally.156 Both Babesia bovis and Babesia bigemina are easily transmitted by subinoculation of infected blood, a fact that forms the basis of vaccination using live parasites. Despite the fact that one parasite inoculated intravenously is capable of inducing infection,79 there is no evidence for iatrogenic transmission or mechanical transmission by biting flies. Intrauterine infection has been reported, but is rare.192
It appears that isolates of Babesia spp. are mixtures of subpopulations differing genotypically and in biological characteristics.47 Selection of different subpopulations or strains may occur during artificial passage in cattle or during growth in vitro causing some of these characteristics to change, including virulence, transmissibility by ticks and immunogenicity. These changes induced by passaging or in vitro maintenance have particular significance in the production and effect of live blood vaccines.20, 51 Cloning experiments have shown these subpopulations to be separable and to differ in virulence, protein profiles and antigenic composition.79, 174 Molecular techniques have also been used to demonstrate changes in Babesia bovis subpopulations with passage and culture.111

Figure 3 Life cycle of bovine Babesia spp.
- = sporozoites released from tick salivary glands
- = sporozoites invade erythrocytes
- = sporozoites in erythrocytes become trophozoites
- = limited merogony (schizogony) whereby a pair of merozoites is produced
- = syngamy follows in the tick gut after ingestion of infected erythrocytes by the engorging female
- = ookinetes penetrate gut epithelial cells and undergo schizogony (merogony) to produce merozoites
- = merozoites (sporokinetes) undergo secondary schizogony (merogony) and also find their way into developing ova (h)
- = oviposition constitutes infected eggs (transovarial transmission)
- = replication in infected larvae by schizogony in the gut of the infected larva
- = sporokinetes eventually invade the salivary glands where they undergo sporogony to produce sporozoites
Repeated serial passages of infected blood exert selection pressures on the parasite populations, which may result in reduced infectivity of Babesia bovis for ticks130, 165 and reduced virulence of both species for cattle.48, 58
The development of Babesia spp. in ticks has been reviewed by Friedhoff.77 Despite many detailed studies, our understanding of the life cycles of Babesia spp. is still incomplete.37 Some of the more recent investigations indicate that sexual reproduction does take place.132 To prevent confusion about the terminology used in the literature to describe different developmental stages in the life cycle, alternatives are given below, in parentheses.
Babesia bovis and Babesia bigemina follow similar developmental patterns in adult Rhipicephalus (Boophilus) spp.77, 152, 157 Initial development takes place in basophilic epithelial cells of the tick gut wall1 where, after reported fusion (syngamy) of gametes in the intestinal lumen, schizogony (multiple fission) occurs with the formation of distinctive, large merozoites (vermicules, sporokinetes)157 (Figure 4) and (Figure 5). Successive cycles of schizogony then occur within a variety of cell types and tissues, including the oocytes.
Thus, transovarial transmission occurs with further development taking place in the larval stage. In the case of Babesia bovis, a final cycle of schizogony (sporogony) takes place within cells in the salivary glands of feeding larvae leading to the formation of small merozoites (sporozoites)152 (Figure 6) and (Figure 7). These small merozoites are infective for cattle (Figure 3). In Babesia bigemina, some development takes place in the feeding larvae, but schizogony in the salivary glands only occurs in the nymphal and adult stages153 (Figure 3).
In cattle, Babesia spp. develop only in the erythrocytes. Each merozoite penetrates the cell membrane with the aid of a specialized apical complex154, 155 (Figure 8). Once inside, it transforms into a trophozoite from which two new merozoites develop by a process of merogony77, 154, 155 (Figure 9). In stained blood films of acutely affected cattle, single trophozoites and typical paired merozoites are readily detected, but dividing forms are less common. Cells containing more than two parasites are rare. Parasitaemias of up to 1 and 5 per cent infected erythrocytes respectively are common for Babesia bovis and Babesia bigemina, but can exceed 20 per cent at the peak of the reaction. Recovered cattle retain a latent infection varying from six months to several years with detectable recrudescences of parasitaemia occurring at irregular intervals.123 The mechanisms used by these parasites to evade immune mechanisms of the host have been reviewed.3
Epidemiology
Numerous factors influence the prevalence of babesiosis. In this discussion, the factors affecting the vector, host and parasite, as well as the concepts of endemic (enzootic) stability and epidemic (epizootic) spread, will be considered.
The distribution of Babesia bovis and Babesia bigemina is determined by the distribution of the vectors (Table 1). Babesia bovis is restricted to areas where R. (B.) microplus, R.(B.) australis, R. (B.) annulatus and perhaps R. (B.) geigyi120 are prevalent. Babesia bigemina is often present over much of the same range as Babesia bovis due to the common vector. However, in Africa, Babesia bigemina is more widespread than Babesia bovis because of the wider range of R. (B.) decoloratus and other vectors, which can survive in drier and cooler areas (see Vectors: Ticks). Recently, R. (B.) microplus has been extending its distribution and establishing itself in areas of Africa in which it has previously not been present,52 and displacing the previously more prevalent R. (B.) decoloratus.93 Thus the potential distribution of Babesia bovis is also expanding. The role of the more drought-resistant vector R. e. evertsi,95 in the epidemiology of Babesia bigemina is unclear.
Inter-specific matings may occur between R. (B.) microplus and R. (B.) decoloratus, resulting in the production of sterile eggs163 and the creation of a ‘hybrid zone’ where populations of the two species overlap.168 The width and stability of this zone are unknown, but it is likely to have a significant effect on the epidemiology of Babesia bovis. The situation is complex and dynamic.93 The reduced vector specificity of Babesia bigemina makes it unlikely that this species will be affected by competition between tick species.
One infected larval tick is sufficient to transmit Babesia bovis, but tick infection rates are usually low and the rate of transmission to cattle is therefore low. Studies in Australia found only 0,04 per cent of field ticks to be infected with Babesia bovis where Bos taurus cattle breeds were involved, and even less in the case of Bos indicus cattle.121, 127 Tick infection rates with Babesia bigemina are higher (0,23 per cent in the Australian study) and therefore transmission rates of this species are also higher than those of Babesia bovis. As a result, Babesia bigemina infections are usually more prevalent in those herds where both species are present57 and less readily affected by factors such as climate or management, which reduce tick numbers.
Babesia bovis and Babesia bigemina have high degrees of host specificity. All cattle breeds may become infected and all develop latent infections after recovery that persist for various lengths of time. Bos taurus breeds of cattle can potentially retain Babesia bovis infections for life35, 142 and remain infective for ticks for up to two years,123 while most cattle with a significant Bos indicus content lose the infection within two years.98 Babesia bigemina infections rarely persist for more than a year, regardless of the host, and infected cattle remain infective for ticks for only four to seven weeks.98, 123 African buffalo (Syncerus caffer) and Asiatic (water) buffalo can develop latent infections.60 Antibodies and transitory infections have also been demonstrated in other animals, but there is little evidence to suggest that nonfamilial hosts are important reservoir hosts60, 104 even though R. e. evertsi infected with Babesia bigemina have been collected off a sable antelope (Hippotragus niger) with clinical babesiosis.80
Both Babesia spp. probably evolved in cattle in the tropics, and well-developed relationships therefore exist between Bos indicus and Sanga cattle and these parasites. As a result, Babesia spp. are generally less important in Bos indicus breeds while Bos taurus breeds are known to be highly susceptible.21, 47 However, literature on the resistance of Bos indicus breeds and crossbred cattle is rather ambiguous.21, 22, 119 In a large controlled field trial in Australia,18 (32 per cent) of 56 pure Bos indicus showed detectable clinical signs after natural exposure to Babesia bovis and Babesia bigemina while only one animal (2 per cent) was severely affected.21 In comparison, 87 per cent of 52 crossbreds (halfbred Bos indicus) were clinically affected, 19 per cent of them severely. Typing of the parasites in severely affected cattle suggested that Babesia bovis was the main cause of the clinical reactions. In a parallel pen trial, Bos indicus and crossbred cattle were more resistant to Babesia bigemina than Bos taurus cattle (none of six Bos indicus and six crossbred cattle was severely affected compared with six of the seven Bos taurus cattle).22
However, susceptibility of individual Bos indicus and crossbred animals varied considerably. The reason for this is unknown but it may help to explain the ambiguity in the literature with regard to breed susceptibility to Babesia bigemina.
African Sanga breeds, although referred to as Bos taurus africanus, are believed to be a composite of taurine and indicine breeds.149 Whilst noted to be well adapted and more resistant to ticks and heat than introduced breeds, they can be quite susceptible to B. bovis infection. In a trial conducted in Australia comparing breed susceptibilities to Babesia bovis, Tuli (a Zimbabwean breed) and Senepol (a composite breed containing N’Dama genetics from Senegal) heifers were just as susceptible to challenge with a virulent Babesia bovis isolate as Charolais and Wagyu heifers.41 Bos indicus heifers (represented by red Brahmans), on the other hand, were quite resistant.
The virulence of Babesia is not a stable characteristic. Mild and virulent isolates of both species have been identified from the field and are known to be capable of rapid change. A major factor in parasite virulence is a history of recent tick transmission; long residence in a bovine reduces virulence while frequent cyclical transmission in ticks may increase the severity of the ensuing reactions.37
Isolates and selected strains of Babesia bovis and Babesia bigemina also differ antigenically47 but this appears to have little epidemiological significance. Cross-immunity experiments have shown that recovered cattle are more resistant to challenge with the same (homologous) isolates than with different (heterologous) ones.47, 60 Antigenic variation is also known to occur during Babesia bovis and Babesia bigemina infections, with variants emerging at regular intervals during the latent phase of the infection associated with slight recrudescences of parasitaemia.60
It is possible to have both Babesia organisms and their vectors present in a cattle population without measurable economic losses or clinical disease. This situation is known as endemic stability and defined as the state where the relationship between host, agent, vector and environment is such that clinical disease occurs rarely or not at all.147 An important factor in the establishment of endemic stability is the age of first exposure. Calves have a natural resistance during the first six to nine months of life and rarely show clinical signs, yet develop solid, long-lasting immunity.47, 60 The occurrence of babesiosis in a herd depends entirely on the frequency with which the causative species is transmitted. If there is frequent transmission, infection of all animals will take place at a young age and immunity will develop without evidence of disease.37, 57, 122
Under conditions of endemic instability, some animals will fail to become infected for a considerable period after birth and will therefore be susceptible to clinical disease. Babesia bovis has lower infection rates in ticks than B. bigemina and endemic instability is therefore more likely to develop to it than to B. bigemina in regions where both are present.56
As examples of this, Babesia bovis was presumed to be absent or endemically unstable in most of southern Africa,56 because a large part of the subcontinent was considered ecologically unsuitable for R. (B.) microplus, the large zone of hybrid interference between R. (B.) microplus and R. (B.) decoloratus, and prevailing tick control measures in the high rainfall areas. More recently, this situation may be changing due to complex interactions of a number of factors, including differences in the biology of these two tick species and changing populations of wildlife and domestic stock.93 Babesia bigemina, on the other hand, is endemically stable in large parts of southern Africa but, where cattle are not exposed at a young age (for example, in situations associated with increasing aridity57 or with increased tick control144 it may become important.
A simple mathematical model has been used to predict the level of stability in a herd.122 It utilizes the rate at which infection occurs in calves (determined serologically at a specific age), thereby providing a means of estimating the status of Babesia bovis infections.56, 122 It has proved useful in predicting stability levels in Bos taurus breeds but less so in those of other breeds. A disease prediction spreadsheet model has also been developed to more accurately calculate incidence risk from age-specific seroprevalence.159 The model predicts the proportion of animals in each age and sex class that would be affected by different severities of the disease, and the information is then converted into a herd model to estimate the number of animals in each severity class. This model has been used to predict the potential impact of Babesia spp. on some large properties in Australia and the cost/benefit of control measures.18
Severe losses may occur when susceptible cattle, especially Bos taurus breeds, are brought into an area where Rhipicephalus (Boophilus) spp. are prevalent. Mortality rates of 5 to 10 per cent are not uncommon under these conditions.57
The distribution of the vectors of Babesia bovis and Babesia bigemina is limited by ecological factors such as rainfall and temperature, and also by the extent of tick control measures. Removal of these barriers may result in the ticks becoming established temporarily or permanently in previously uninfested areas.
It is interesting that introduction of R. (B.) microplus in the latter half of the nineteenth century into Australia resulted in a major epidemic of babesiosis37 paralleling the southern African experience with East Coast fever. This raises the question why the same did not happen when R. (B.) microplus was introduced into southern Africa. Some possible explanations are that Babesia bigemina was already present and therefore only Babesia bovis was associated with the spread of R. (B.) microplus; competitive interference by R. (B.) decoloratus suppressed R. (B.) microplus in some areas; the East Coast fever campaign in the early part of the twentieth century prevented the unchecked spread of R. (B.) microplus; and Babesia bigemina gave partial protection against the introduced Babesia bovis.
Immunology
Calves less than two months old born to previously unexposed cows are susceptible to infection and the effects of the disease,37 while offspring of immune mothers are resistant, presumably because of a passive transfer of immunity via the colostrum.60, 187
After the age of two months a natural, non-specific, innate resistance, which persists for at least a further four to six months and is not dependent on the immune status of the cow, protects calves.37, 177 The innate response in the spleen of calves exposed to a primary Babesia bovis infection involved earlier and higher expression of interleukin (IL)-12, interferon (IFN)-γ and nitric oxide (NO), and regulation of the NO response, compared to the delayed response in the adult spleen.26
Severe attacks of babesiosis in cows at calving have been observed, and may be related to the perinatal immunosuppression that occurs in other host-parasite systems.137
Most cattle develop a durable immunity after recovery. This immunity is not absolute but may last for life, even in the absence of reinfection. Following recovery, the infection persists for varying periods in a latent form without detriment to the host. The presence of this latent infection, known as premunity, was long considered to be a prerequisite for protective immunity.142 It is now known that persistence of infection is not necessary to ensure immunity. For instance, cattle that naturally eliminate the infection retain strong and lasting immunity,20, 98, 118 while cattle cured of the infection by drugs show levels of resistance more closely related to the degree and duration of antigenic stimulation than to the presence of parasites.39, 118 The concept of premunity in Babesia infections has therefore been abandoned. No evidence of a loss of immunity with time was noted in Australia after use of the Australian tick fever vaccine.15
The quality and duration of the resistance to reinfection after recovery is not affected by the age of the host at the time of initial infection, nor by the virulence of the strain involved.37, 125, 126 Cattle recovered from Babesia bigemina infections show some resistance to Babesia bovis challenge,189 but the reverse is not true.
The mechanisms of immunity in babesiosis are complex and involve both antibody and cell-mediated components.26 Antibodies develop after infection, but not all are protective and attempts to correlate antibody levels with immunity have failed.39, 122 However, some indirect evidence for a protective role for antibodies is provided by the passive transfer of maternal immunity to Babesia bovis and Babesia bigemina in calves by colostrum intake,60, 187 and the protection provided when immune serum was transferred to naïve calves.16, 75 Live Babesia bovis inoculated into cattle induce antibodies that remain at high levels for at least six months.175
A model of protective immune mechanisms for Babesia bovis infection 26 proposes a two-staged response: an initial strong innate response that involves activation of macrophages via IFN-γ and parasite-derived factors, with parasite destruction occurring via phagocytosis and production of toxic metabolites by macrophages; and then in persistently infected animals (after natural infection or vaccination), protection against clinical disease depends on memory and effector CD4+ T cells, with production of cytokines, including IFN-γ, which enhance antibody production by B cells.
Specific and non-specific cell-mediated mechanisms involving T lymphocytes and natural killer (NK) cells appear to be involved in laboratory Babesia infections. Intracellular death of parasites occurs that is not caused by antibodies and is nonspecific, with other parasites, micro-organisms and even microbial extracts exerting the same effect on rapidly dividing Babesia organisms. A possible explanation of this phenomenon is the nonspecific action of NK cells activated by either a specific immune response involving lymphocytes, or by nonspecific agents.60
Macrophages are important for immunity to Babesia bovis because they act as antigen-presenting cells (APC) for T helper (Th) lymphocytes and remove parasitized erythrocytes by phagocytosis. Macrophages activated by IFN-γ are thought to play a significant role in resistance to Babesia bovis by parasite suppression via secretory products released from macrophages.188 This has been demonstrated in vitro where supernatant from macrophages stimulated with Babesia bovis antigens inhibited the growth of B. bovis.137
The generation of reactive nitrogen intermediates (RNI), such as NO, or reactive oxygen intermediates (e.g.H2O2), is a mechanism whereby activated macrophages release microbicidal products. NO has been shown to be produced by bovine macrophages following stimulation either with Babesia bovis merozoites or with antigen-stimulated Babesia bovis-immune T lymphocytes.166 NO has also been shown to inhibit the growth of Babesia bovis in vitro whilst H2O2 does not.97 The effect of NO appears to be directly on the parasite and not on the erythrocytes.
There is no direct evidence that Babesia bovis-specific T lymphocytes are protective because adoptive transfer studies using T lymphocytes from immune animals are difficult to perform in cattle. Indirect evidence, however, suggests that T lymphocytes are important for immunity. In many protozoal infections, T lymphocytes are the primary effector cells in protective immunity.71, 107 Peripheral blood mononuclear cells from immunized cattle exhibit weak and short-lived proliferative responses to a crude soluble parasite extract;173 however, they may proliferate in response to merozoite membrane antigen for up to two years after infection.29 Brown and co-workers studied T lymphocytes from cattle immune to Babesia bovis in an effort to identify antigens of Babesia bovis that may induce protective immunity.29 They showed that CD4+ T lymphocytes (Th lymphocytes), but not CD8+ T lymphocytes (T suppressor lymphocytes) or γδ T lymphocytes, are preferentially stimulated by crude parasite antigens in vitro.28 Further work analysing cytokine profiles of Th lymphocyte clones derived from immune animals has shown that IFN-γ, IL-2, IL-4 or tumour necrosis factor (TNF) may be produced in response to in vitro Babesia bovis stimulation.32
The role of the spleen in immunity to babesiosis is well known.60 Splenectomy of latent carriers usually results in fatal Babesia bigemina relapses and in Babesia bovis relapses that are sometimes fatal. Infection of susceptible splenectomized cattle results in fulminating infections with both parasite species. Splenic lesions have been shown to reduce the ability of intact calves to contain attenuated Babesia bigemina infections.68 The spleen is not essential for the development of protection, but immunity is established more rapidly in intact than in splenectomized animals, suggesting that localization of immune cells in the spleen and the splenic microcirculation facilitates the process.82
Pathogenesis
Babesia bovis infection
The acute disease is characterized by a hypotensive shock syndrome with vascular stasis and accumulation of parasitized red blood cells in the peripheral circulation. It is accompanied by activation of a coagulation/complement cascade and the release of vasoactive compounds resulting in vasodilation and circulatory stasis as well as generalized organ damage due to anoxia and toxic products of both parasites and damaged host tissue.188
Parasite proteases cause hydrolysis of fibrinogen, which results in the accumulation of large quantities of soluble fibrin complexes that are not cross-linked, as well as in altered fibrinogen in the circulation. Thus, the coagulability and viscosity of blood increases but insoluble fibrin is evidently not produced, suggesting that classic disseminated intravascular coagulopathy is not a feature of Babesia bovis infections.186
The molecular mechanisms behind the process of cytoadherence162 and sequestration in Babesia bovis infections are still only poorly defined.85 While Babesia bovis and Plasmodium falciparum share similar attributes of rapid antigenic variation and cytoadherence, it seems that findings for Plasmodium spp. are not directly transferable to Babesia bovis infections.4, 85
Parasite proteases also activate macrophages to release pharmacologically active agents, such as histamine and 5-hydroxytryptamine, causing vasodilation, hypotension, increased capillary permeability, oedema and vascular collapse.185 This hypotensive shock state has much in common with endotoxic shock, suggesting that Babesia bovis and endotoxin cause macrophages to activate the same harmful mediators.43, 44, 185 In fact, the susceptibility of laboratory animals to endotoxin increases dramatically after they have been infected with Babesia spp..44 Laboratory evidence also suggests that Babesia spp. cause leukocytes to release free oxygen radicals.44 These radicals are toxic and contribute to endothelial damage, thus augmenting the effects of circulatory stasis and hypotension.44, 188
Progressive haemolytic anaemia develops during the course of Babesia bovis infections. While this is not a major factor during the acute phase of the disease, it will contribute to the disease process in more protracted cases.
Babesia bigemina infection
Pathogenesis is almost entirely related to rapid, sometimes massive, intravascular haemolysis.37 Coagulation disorders and the hypotensive state seen in acute Babesia bovis infections are not features of Babesia bigemina infections.49, 186
Clinical signs
The clinical signs that develop as a result of Babesia bovis and Babesia bigemina infections are similar, but the course and outcome are often very different.37 The incubation periods of natural infections usually vary from 8 to 15 days.91
Babesia bovis infection
In acute infections, fever (>40°C) is usually present for several days before other signs become obvious. This is followed by inappetence, depression, weakness and a reluctance to move. Haemoglobinuria is often present as the disease progresses; hence the name redwater. Anaemia and icterus develop and are especially obvious in more protracted cases. Diarrhoea is common and cows may abort. Muscle wasting, tremors and recumbency develop in advanced cases and are followed by coma in terminal cases. Affected animals may die from one to several days after the onset of clinical signs. Non-fatal cases may take several weeks to regain condition but recovery is usually complete.37 Surviving bulls may show reduced fertility lasting six to eight weeks as a result of the fever.72
Cerebral babesiosis, due to adhesion and accumulation of infected erythrocytes in the brain capillaries, develops in some Babesia bovis infections and is manifested by a variety of signs of central nervous system involvement. These include hyperaesthesia, nystagmus, circling, head pressing, aggression, convulsions and paralysis, and may or may not accompany other signs of acute babesiosis. The course of the disease is usually short and the outcome is almost invariably fatal.
In subacute Babesia bovis infections, clinical signs are less pronounced and sometimes difficult to detect. Calves infected before they reach eight months of age often develop an inapparent form of the disease.37
Babesia bigemina infection
Acutely affected cattle are usually not as severely affected as those with Babesia bovis infections, but the disease can develop very rapidly with sudden and severe anaemia, icterus and death, which may occur with little warning.17, 49 Haemoglobinuria is present earlier and more consistently than in Babesia bovis infections. Signs of cerebral involvement are not seen and recovery in non-fatal cases is usually rapid and complete.
Pathology
Clinical pathology
Babesia bovis infection
Haemolytic anaemia, which is characteristically macrocytic and hypochromic, is a feature of Babesia bovis infections. Packed cell volumes (PCV) may fall to less than 0,10, total erythrocyte counts to less than 3,0 × 106/ ml, and total haemoglobin to less than 50 g/l.37, 184 Severe anaemia is particularly evident in protracted cases, while very acute cases may die with little evidence of anaemia.
In cattle that survive the infection, parasitaemia levels start to fall three to five days after the onset of patency (the first microscopic detection of parasites), and evidence of a response indicative of erythrocytic regeneration can be detected two to four days later. These signs include anisocytosis, polychromasia, punctate basophilia, macrocytosis and reticulocytosis.37 Recovery is slow and it may take several weeks before normal red blood cell counts are restored. Leukocytic changes are variable, ranging from leukopenia to leukocytosis.194
Changes in blood chemistry reflect the consequences of circulatory stasis and hypotension, including renal and liver damage, and muscle degeneration.186 Characteristically, the following occur:182, 184, 188, 191, 194
- significant increases in blood urea nitrogen and plasma creatinine levels;
- marked increases in unconjugated bilirubin levels, plasma creatine kinase and lactate dehydrogenase levels;
- the presence of haemoglobin in the serum to a level that may be as high as 5 g/l;
- increased plasma concentrations of fibrinogen and soluble fibrin;
- proteinuria during the acute phase of the infection of which 15 to 20 per cent is haemoglobin and 70 to 75 per cent albumin;
- metabolic and respiratory alkalosis as shown by elevated bicarbonate, excess base levels and a lowered pCO2; and
- a terminal increase in lactate and pyruvate levels.
Babesia bigemina infection
Haemolytic anaemia is the outstanding feature and is very similar to that seen in Babesia bovis infections. However, red blood cell destruction occurs more rapidly in severe cases and is accompanied by a precipitous fall in PCV, red blood cell count and haemoglobin value. Osmotic fragility of the red blood cells increases during the acute phase of the infection,186 and serum haemoglobin levels are high in acute cases. Evidence of kidney and liver damage is similar to that seen in Babesia bovis infections.184
Macroscopic and microscopic pathology
Babesia bovis infection
In acute infections, congestion of most organs and tissues is intense, with subserosal petechiae and ecchymoses occurring in many internal organs. Conversely, protracted cases show evidence of anaemia and icterus. Haemoglobinuria is often seen at necropsy as a light to dark red discoloration of the urine.
The spleen is commonly enlarged, sometimes to several times its normal size. The liver is swollen and may be yellowish-brown, with the gall bladder containing copious amounts of thick granular bile. The kidneys and lymph nodes are also enlarged. Pulmonary oedema may be present but is uncommon. In the cerebral form of the disease, the grey matter of the cerebrum and cerebellum has a characteristic cherry-pink colour (Figure 10).17, 37, 160, 190
Microscopically, sequestration of parasitized red blood cells in the peripheral circulation (Figure 11) and evidence of vascular stasis are striking in acute Babesia bovis infections. Large numbers of parasitized red blood cells fill the capillaries, sinuses and sinusoids of various organs, and can even pave the intima of larger blood vessels. Accumulations of haemosiderin and phagocytosed red blood cells, sometimes containing parasites, are common in cells of the reticuloendothelial system, especially in the spleen, liver and lymph nodes.17, 160, 184 Other lesions include:37, 160, 184
- degeneration and necrosis of the epithelium of the convoluted tubules in the kidneys and an accumulation of hyaline or granular casts in the tubular lumens;
- centrilobular hydropic or fatty degeneration to extensive centrilobular and midzonal hepatic necrosis and bile stasis;
- marked congestion of the sinusoids of the spleen and a reduced ratio of white to red pulp with the germinal centres containing few cells;
- oedematous and congested sinuses in the lymph nodes and depletion of lymphocytes in the germinal centres;
- oedema of the lungs in some cases;
- marked distension of the capillaries of the brain by parasitized red blood cells (perivascular haemorrhages are uncommon);
- haemorrhages in the myocardium and hyaline degeneration of some myocytes; and
- degeneration of skeletal muscle fibres in the hind limbs.
Ultrastructurally, capillaries in the brain are dilated and filled with closely packed red blood cells, most of which are parasitized. These red blood cells have scalloped edges with fine strands apparently connecting adjacent red blood cells, as well as connecting erythrocytes and endothelial cells (Figure 12). Masses of red blood cells that have undergone lysis but still contain intact parasites are frequently seen in capillaries. Changes in the capillary endothelium of the affected parts in the brain range from swelling of the cytoplasm and nucleus to necrosis. Perivascular and perineuronal spaces are enlarged.183
In the kidneys, capillaries are not packed as tightly with red blood cells as in the brain. Other changes are similar to those seen in the brain. Capillaries in the lungs are packed with red blood cells, but only a small proportion of the cells are parasitized.190
Babesia bigemina infection
Lesions seen at necropsy resemble those in animals that have died after an anaemic crisis. There is evidence of severe haemolysis, such as a pale carcass, watery blood and haemoglobinuria. Haemorrhages in internal organs and splenomegaly are not as marked as in Babesia bovis infections, but pulmonary oedema is a common finding. Icterus is evident in protracted cases.17, 37
Histological changes are less pronounced than in Babesia bovis infections, and sequestration of infected red blood cells and vascular stasis are not features of the infection. Changes in the kidneys and liver are similar to those caused by Babesia bovis. Extensive necrosis of the red pulp of the spleen is common and large thrombi may be present.17, 184
Immunopathology
Evidence of auto-antibodies as mediators of anaemia in babesiosis comes mainly from experimental studies with laboratory infections of Babesia spp.. In bovine babesiosis, however, anaemia closely parallels the parasitaemia and there is no evidence of auto-immune anaemia having a significant pathogenic role, even though phagocytosis of non-parasitized erythrocytes is known to occur.47
Immune complexes have been implicated as a cause of the anaemia, splenomegaly and glomerulonephritis in Babesia models in the laboratory, but their contribution to the disease in cattle has not been conclusively established.47, 60 Babesia bovis antigen has been detected in glomeruli and the endothelium of blood vessels, and is known to be intimately associated with host fibrinogen.87
Immune responses to heterologous antigens are suppressed during Babesia infections. The most convincing evidence of this immunosuppression comes from laboratory Babesia models. It is manifested by an impaired ability of the host to counter superimposed parasitic and other infections, as well as by decreased antibody responses to inoculated antigens.47, 60 Babesia bovis causes a prolonged increase in the susceptibility of cattle to R. (B.) microplus infestation if the host is exposed to both parasites at the same time.36 Cortisol values also become markedly suppressed during Babesia bovis infections and may be followed by transient adrenocortical dysfunction.70
Diagnosis
History, clinical signs and macroscopic lesions may often be suggestive of babesiosis, yet are not absolutely characteristic of the disease. Differentiation between Babesia bovis and Babesia bigemina infections is also impossible on these grounds but is important because of differences in pathogenesis, prognosis and control.
The traditional method of identifying the agent in infected animals is by microscopic examination of thick and thin blood films stained with, for example, Giemsa’s stain.17 Details of these techniques are recorded in the literature and the sensitivity is such that parasites can be detected in most clinically affected animals.145 Species differentiation is good in thin films but poor in the more sensitive, thick films. This technique is usually adequate for detection of acute infections but is not suitable for detection of carriers, where the parasitaemias are usually well below levels detectable by microscopy. Parasite identification and differentiation can be improved by using a fluorescent dye, such as acridine orange, instead of Giemsa’s stain.76
For the best results, blood films should be prepared from capillary blood collected, for instance, after pricking the tip of the tail or margin of an ear. The temptation to use blood of the general circulation should be resisted as these specimens may contain up to 20 times fewer Babesia bovis than capillary blood.17 In Babesia bigemina infections, parasitized cells are evenly distributed throughout the blood circulation. Mixed infections of the two Babesia spp. are uncommon. Babesia bovis parasitaemias are often low (<0,1 per cent infected erythrocytes), even at the peak of the reaction, while Babesia bigemina parasites are usually more numerous and therefore easier to detect. The most common method of staining these films is to apply Giemsa’s stain at 10 per cent in phosphate buffered saline or Sorensen’s buffer (pH 7,4) for 15-30 minutes after fixation in absolute methanol.17, 145
Thick blood films are especially useful for the detection of low level B. bovis infections,17 although are likely to be most useful as a research tool. When making thick films, the blood is not spread over a large area, thereby concentrating the parasites, and is not fixed with methanol before staining, thus allowing lysis of the red blood cells. These films are also stained with 10 per cent Giemsa’s solution for 15-30 minutes.
Several factors may make it either difficult or impossible to identify Babesia spp. in blood films from animals with suspected babesiosis: prior treatment of the animal with a babesiacide will cause the parasites to degenerate and disappear, often within 24 hours; exposure of the films to moisture or formalin will make identification of the parasites difficult; and contamination of smears by dirt or bacteria may mask the presence of parasites.17
Diagnosis at necropsy is possible if decomposition is not too advanced. The specimens should include thin films of blood from the peripheral and general circulation, a squash preparation of a small piece of cerebral cortex and impression smears, in order of preference, of kidney, heart muscle, liver, lung and spleen. These are stained in the same manner as blood films. Babesia parasites assume a round shape within a few hours of death, thus making differentiation of species difficult on the basis of morphology alone.
However, vast accumulations of parasites in organ smears, or big differences in the parasitaemias of the general and peripheral circulations, are indicative of Babesia bovis infections. In Babesia bigemina infections, parasites are readily detected in the general circulation. Accurate diagnoses are usually possible as long as intact erythrocytes are recognizable in the preparations. In cool weather this may be as long as three days after death.17, 62, 76
For histopathological examination, specimens of brain, kidney, liver, lung and spleen should be submitted. Babesia bovis will be identifiable by virtue of its accumulation in the capillaries of organs, but a diagnosis of Babesia bigemina may be difficult to confirm unless the parasitaemia is very severe.
Labelling of parasites with fluorescein or horse-radish peroxidase conjugated anti-Babesia bovis and anti-Babesia bigemina IgG is a sensitive, specific laboratory tool to identify parasites in blood and organ preparations, provided adequate numbers of parasites are present.99, 108 Probes have also been used to detect DNA of bovine and other Babesia spp. but are generally not more sensitive than direct microscopy and application in routine diagnostics is limited.24, 76 PCR assays soon proved to be very sensitive, particularly in detecting Babesia bovis and Babesia bigemina in carrier cattle.34, 47, 74 Increased understanding of the parasites85 and the rapidly expanding suite of molecular tools means that molecular diagnostic methods are still evolving and being optimised. Such methods include real-time PCR (qPCR), reverse line blot hybridisation (RLB) and loop mediated isothermal amplification (LAMP).139 However, molecular diagnostic methods are unlikely to supplant serological tests as the method of choice for epidemiological studies. Molecular diagnostic assays may be useful as confirmatory tests, in research, in some cases for regulatory testing, and also as markers for vaccine strains.23
In vitro culture methods have been used to demonstrate the presence of carrier infections of Babesia spp..92, 195 The minimum parasitaemia detectable by this method will, to a large extent, depend on the facilities available and the skills of the operator24 but could be as low as 10−10, making it a very sensitive method for the demonstration of infection.76 An added benefit is that it is 100 per cent specific. Intravenous inoculation of a large volume of blood from a suspected carrier into a splenectomised calf known to be Babesia-free can also be used as a means of confirming infection.17
A variety of serological tests have been used to demonstrate the presence of antibodies to Babesia spp.. Of these, the indirect fluorescent antibody (IFA) test has been widely used in the past to detect antibodies to Babesia.25, 40, 113 Apart from some cross-reactivity problems, disadvantages of the IFA included low sample throughput and operator subjectivity.145
The IFA test has now been largely replaced by enzyme-linked immunosorbent assays (ELISAs) for the diagnosis of Babesia bovis infection. The initial assays used whole merozoite antigens,53, 135, 180 but indirect and competitive ELISAs based on recombinant antigens have now been developed42, 145 Several of these tests have been more widely validated.80, 135
Competitive ELISAs based on purified and recombinant antigens and monoclonal antibodies have overcome some of the specificity issues associated with Babesia bigemina crude antigen,81, 136, 145 but remain less widely validated in general. Antibody levels after Babesia bigemina infection have been noted to decline below the negative threshold within a few months in some cases.81
Differential diagnosis
The diagnosis of suspected clinical cases of babesiosis showing fever, haemoglobinuria, anaemia and icterus, should be confirmed by demonstrating the parasites microscopically in erythrocytes. Efforts should be made to differentiate between Babesia bovis and Babesia bigemina infections, as specific diagnoses lead to a better understanding of the epidemiology with regard to species distribution, prevalence in specific areas, and their respective importance in disease outbreaks. Disease control strategies certainly benefit from such recorded information.
Species differentiation is essential in handling babesiosis outbreaks as it influences the choice of prophylactic treatment to be used, and the recommendations for appropriate follow-up vaccination programmes.
Babesiosis should be differentiated from anaplasmosis in animals showing anaemia and icterus, especially in the absence of haemoglobinuria. Positive identification of parasites in blood smears, especially Anaplasma spp., may be difficult in advanced cases because of massive haemopoiesis and low numbers of parasites at this time. It is common practice in some areas to treat such clinical cases with drugs directed against both babesiosis and anaplasmosis.
Haemolysis, haemoglobinuria and icterus may also occur in cattle suffering from leptospirosis, as well as from non-infectious conditions such as chronic copper poisoning and various plant toxicities.
Cerebral babesiosis caused by Babesia bovis can be confused with other nervous conditions in cattle, such as heartwater, cerebral theileriosis, sporadic bovine encephalomyelitis (caused by Chlamydophila pecorum), various plant poisonings, chlorinated hydrocarbon pesticide poisoning, vitamin B1 deficiency responsible for cerebrocortical necrosis, and bacterial meningitis and meningoencephalitis (such as infections with Histophilus somni (formerly Haemophilus somnus), Pasteurella spp. and Streptococcus spp.).
It is often speculated that new infections or stress might ‘revive’ a latent infection of different haemotropic parasites, because mixed infections of Theileria, Babesia and Anaplasma spp. are frequently encountered in blood smears of clinically affected animals. This remains speculative and has not yet been studied adequately or resolved.
Control
There are several options for control of tick-borne diseases. Eradication of the tick vectors is the most desirable, permanent solution to the problem but is rarely considered practical or economical on either a national or local basis.13
The alternative approach of allowing natural endemic stability to develop by practising limited or no tick control is similarly unrealistic in some areas, especially where tick vectors of other major diseases (for example R. appendiculatus and Amblyomma spp.) are well established.148 In regions also endemic for Rhipicephalus (Boophilus) spp., essential control of other tick species will inevitably affect the epidemiology of babesiosis. It is recognized, however, that the livestock industries can be guided along cost-effective pathways by ‘managing’ the ticks and diseases associated with them.13, 167 In the long term, this approach can be achieved by integrating the strategic use of acaricides, the application of vaccines in endemically unstable conditions and the use of tick-resistant breeds of cattle.13
Tick control
Control of ticks as a method of preventing babesiosis is feasible in situations where ticks have made temporary incursions into environments that are normally unsuitable for their long-term survival.57 Many farmers in regions endemic for Rhipicephalus (Boophilus) spp. also believe that very few or no ticks should be seen on cattle.67 However, on the basis of cost and benefit, tick control in these regions for the purpose of preventing babesiosis can rarely be justified.131 It can be difficult to prevent the occurrence of babesiosis by tick control alone. Many contact acaricides, with which the animal is saturated and the ticks are killed on contact, have a very short residual action, meaning cattle may pick up more ticks soon after application. Systemic acaricides (for example, fluazuron and the macrocyclic lactones) administered by topical application or injection do not kill the immature ticks rapidly enough to prevent transmission of Babesia bovis or, in the case of injectable formulations, B. bigemina.179
Vaccination
Cattle develop a durable immunity after a single infection with Babesia bigemina and Babesia bovis. This feature has been exploited in some countries with the use of live attenuated vaccines to immunize cattle.16, 63, 75 These vaccines have traditionally been produced over the years in government supported laboratories as services to the livestock industries, amongst others in Argentina, Australia, Israel and South Africa.75
Early babesiosis vaccines involved carrier–donor systems whereby blood of recovered carriers was used as vaccine. These vaccines were simple to produce but suffered from variable infectivity and poor quality control in general.
Considerable progress has been made in the setting of international standards for the production and quality control of Babesia vaccines.145 The Babesia vaccines available in the various countries all differ slightly in attributes, but the essential process and features of the vaccines are similar. The selected Babesia vaccine strains are field isolates that have been attenuated by passage in splenectomised calves; some have been adapted to in vitro culture systems. The organisms for production of vaccine are obtained by harvesting infected RBCs from splenectomised calves or the in vitro culture systems, and the vaccines are manufactured either as a chilled vaccine for immediate despatch or a frozen vaccine stored in liquid nitrogen for future use.16, 63, 128, 151
The strains of Babesia bigemina and Babesia bovis used in the vaccine are of reduced virulence, but are not entirely safe. Reactions to Babesia bigemina may be seen within seven days and to Babesia bovis within 10 to 21 days, but this may vary with the vaccine strain. A practical recommendation is therefore to limit the use of vaccine to calves when non-specific immunity will minimize the risk of reactions. When older animals have to be vaccinated, there is a risk of severe vaccine reactions. These reactions occur infrequently, but valuable animals obviously warrant close attention, and should be observed daily for three weeks after vaccination. Because of the risk of abortions, vaccination of pregnant cows may not be advised, but this advice may vary depending on the virulence of the vaccine strain used. Introduction of susceptible cattle to a Babesia-endemic area may carry more risk of clinical disease than the risk associated with vaccine reactions. Ideally, rectal temperatures of vaccinated susceptible cattle should be taken and animals treated if significant fever develops. Alternatively, recently vaccinated susceptible animals should be monitored for signs of depression or lethargy in the weeks after vaccination. Prophylactic treatment, including use of low doses of babesiacides, tetracyclines and aminoguanidine have also been used to reduce (‘block’) the prevalence of vaccine reactions.65, 78, 101 However, concurrent use of such drugs interferes with development of immunity to the vaccine, and such blocking treatments are no longer recommended.57, 61, 63
The main features of the live babesiosis vaccines are as follows:
- Protective immunity develops in four to six weeks.
- The immunity lasts for several years in the case of Babesia bovis,57 but in the absence of natural challenge, it may break down in the case of Babesia bigemina.142 However, the latter does not seem to pose a problem under field conditions and revaccination is therefore rarely advocated.
- Babesiosis vaccines can in general be given at the same time as anaplasmosis and other vaccines, but specific recommendations should be clarified.
- Attenuated strains of Babesia bovis and Babesia bigemina impart a high degree of immunity to other strains, even in other countries and continents.25, 58, 59
- Factors influencing the development of protective immunity include viability and storage of the vaccine, development of ‘breakthrough’ field isolates and poor immunogenicity of the vaccine strain and, in some circumstances, poor responsiveness of the vaccinated animals.20
- Quality assurance protocols are needed to ensure not only acceptable infectivity and immunogenicity of the vaccine, but also to eliminate the risk of transmitting other blood-borne infections.145
Details on the use of babesiosis vaccines are provided by the various manufacturers in the instructions with the vaccine.
The technical and biological shortcomings of these live vaccines include short shelf life of the chilled vaccines; animal welfare implications for the donor calves; the risk of transmission of the vaccine strain by ticks in some countries16 and potential reversion to virulence; liquid nitrogen storage and transport for the frozen vaccine; and the risk of transmission of other infectious agents. These factors have provided impetus to improve the vaccines and also to develop inactivated vaccines.
A detailed review of the current state of and work towards the development of improved Babesia vaccines is available.75 Experimental vaccines containing crude or purified Babesia antigens extracted from infected cattle or cultures have been developed but the level and duration of protection against heterologous challenge have varied.11, 47, 138 Progress in the development of recombinant vaccines has been hampered by polymorphism among isolates and species, and a lack of knowledge of the immune effector mechanisms responsible for protection against haemoparasitic diseases,140, 146 but antigens that stimulate strong anamnestic immune responses have been identified31. Many challenges remain, however, despite the increasing availability of parasite genomes and bioinformatics tools, which should aid understanding of the biology of the Babesia spp. and help identify various diagnostic and vaccine candidates.26, 75, 85 For any recombinant vaccine to be successful in a practical sense, it should produce an immunity that is at least comparable to that of the live vaccines in degree of protection as well as the longevity of the immunity. No killed or recombinant vaccines were available in the year 2017 for routine use against Babesia bigemina and Babesia bovis.
Treatment
A number of compounds have been used over the years to treat babesiosis, some of which are shown in (Table 2). Unfortunately, none is ideal for the purpose and while some of the diamidine compounds have proven to be both safe and effective, problems with residues have affected availability in some countries, and potentially also export markets for beef and dairy products in others. Some products may now not be commercially available. Dose rates and instructions of the manufacturers must be adhered to at all times. The chemotherapy of babesiosis is comprehensively reviewed in the literature.8, 109, 110, 139
Drug resistance in bovine Babesia spp. has not been confirmed. Some tolerance by Babesia bovis to imidocarb has been reported,46 but this did not affect the therapeutic value of the drug.
Recovery is the rule if specific treatment is given early in the course of the infection. However, if treatment is delayed, other supportive therapy may be essential.
Table 2 Chemotherapy of bovine babesiosis
| DRUG | TRADE NAME | DOSAGE AND ROUTE OF ADMINISTRATION* | USES AND ADVANTAGES | DISADVANTAGES |
| DIAMIDINE DERIVATIVES | ||||
| Diminazene | Berenil | 3,5 mg/kg i/m | Rapid activity against both Babesia spp.; well tolerated | |
| Ganaseg | ||||
| Trypazen | ||||
| Veriban | ||||
| Babezene | ||||
| Dimisol | ||||
| Amicarbalide | Diampron Pirodia | 5–10 mg/kg s/c, i/m | Rapid activity against both Babesia spp.; well tolerated | |
| Imidocarb | Imizol | 1,2–3,0 mg/kg s/c or i/m | Rapid activity against both Babesia spp.; well tolerated | Nephro- and hepatotoxic at high doses |
| Phenamidine | Phenamidine | 12 mg/kg s/c or i/m | Greatest activity against B. bigemina | Cholinesterase inhibition |
| QUINOLINE DERIVATIVES | ||||
| Quinuronium sulphate | Babesan | 1 mg/kg s/c | Greatest activity against B. bigemina | Slow effect on B. bovis. Cholinesterase inhibition: dose rate should not be exceeded (atropine counteracts toxic effects) |
| Ludobal | ||||
| Acaprin | ||||
| Pirevan | ||||
| ACRIDINE DERIVATIVES | ||||
| Euflavine | Gonacrine | 2–4 mg/kg i/v | Rapid activity against both Babesia spp. | Highly irritant if not given strictly i/v |
| Euflavine | ||||
| Trypan blue | Trypan blue | 0,1 mg/kg i/v | Active against B. bigemina | Little effect against B. bovis, irritant if not given i/v; discoloration of milk and carcass |
| Antibiotics | ||||
| Tetracycline | Terramycin LA | 20 mg/kg i/m | Mitigates Babesia vaccine reactions | Doubtful efficacy in clinical disease |
* i/m = intramuscular; s/c = subcutaneous; i/v = intravenous
Non-specific suport includes the use of haematinics, vitamins, antipyretic drugs, intravenous administration of fluids,139 good nutrition and provision of shade. Blood transfusions may be indicated in cattle with high parasitaemias and low PCVs (<0,10); reactions are seldom seen at the first transfusion. In acute Babesia bovis infections, high doses of corticosteroids may help to offset the hypotensive and hypercoagulable state of the animal.22
Chemoprophylaxis
Imidocarb and diminazene are the only babesiacides with useful prophylactic properties for the short-term control or prevention of babesiosis. Treatment with imidocarb (3 mg/ kg) will prevent overt B. bovis infections for at least four weeks and Babesia bigemina infections for at least eight weeks9, 169 Diminazene (3,5 mg/kg) will protect cattle against the two diseases for one and two weeks respectively.9
Short-term control of outbreaks by chemoprophylaxis may be valuable, particularly if the morbidity rates are high. Treatment of all affected and exposed cattle will be costly but will bring about rapid, although temporary, relief.57
It is also useful when susceptible cattle are transported through or temporarily reside in an endemic area, and when pregnant cows need temporary protection.57
The use of prophylactic compounds may be combined with an intensive dipping programme aimed at eradicating the vector ticks, or with subsequent vaccination to stabilize the situation.57 Unfortunately, the prophylactic use of imidocarb may interfere with the development of immunity following vaccination because the residual effect of the drug may eliminate or suppress the infection.57, 61, 63 The interval between the use of imidocarb and vaccination should be at least eight weeks if immunity to Babesia bovis is required and 16 weeks in the case of Babesia bigemina. If diminazene is used, the intervals for the two parasites should be about four and eight weeks respectively.9, 63
Genetic resistance
It is well known that Sanga and Bos indicus breeds are better adapted to cope with tick infestation than European Bos taurus breeds, and are considered to have a degree of natural resistance to babesiosis. This has, no doubt, contributed to the popularity of Sanga breeds such as the Afrikaner, Nguni and Mashona in Africa and Bos indicus breeds generally in endemic parts of the world. The resistance of these cattle, however, is not absolute and significant losses can result from exposure to babesiosis, particularly for breeds which are composites of Bos taurus and Bos indicus genotypes, such as African Sanga breeds.41, 149 While the literature on the topic is conflicting, it is clear that pure Bos indicus cattle have a high degree of natural resistance to Babesia bovis and Babesia bigemina infections while crossbred cattle are sufficiently susceptible to warrant preventive measures.19, 21, 22 Using Ramsay’s disease prediction model126 on data from Queensland,14 the benefit to cost ratio of vaccination is very favourable in the case of Bos taurus cattle. It is also mostly favourable for crossbred cattle except at very high seroprevalence levels in young cattle.
Control of outbreaks
Procedures to be followed during an outbreak will depend largely on the number and manageability of the animals concerned, and the availability and cost of labour, drugs, vaccine and acaricides. One or more of the following actions can be taken to limit losses:9
- Treat sick animals and separate them, if possible, from the rest of the herd.
- Have the diagnosis confirmed at a reputable laboratory.
- Treat unaffected cattle for ticks to prevent exposure.
- Consider immediate vaccination of all unaffected cattle.
- Consider use of a prophylactic treatment programme as mentioned above.
References
- AGBEDE, R.I.S., KEMP, D.H. & HOYTE, H.M.D., 1986. Secretory and digest cells of female Boophilus microplusem: Invasion and development of Babesia bovis; light and electron microscope studies. In: SAUER, J.R. & HAIR, J.A., (eds). Morphology, Physiology and Behavioural Biology of Ticks. Chichester, U.K. Ellis Horwood Ltd.
- AKTAS, M., OZUBEK, S. & VATANSEVER, Z., 2014. Molecular evidence for trans-stadial and transovarial transmission of Babesia occultans in Hyalomma marginatum and Rhipicephalus turanicus in Turkey. Veterinary Parasitology, 204(3-4), 369-371.
- ALLRED, D. R., 2003. Babesiosis: Persistence in the face of adversity. Trends in Parasitology, 19(2), 51-55.
- ALLRED, D. R. AND B. AL-KHEDERY., 2004. Antigenic variation and cytoadhesion in Babesia bovis and Plasmodium falciparum: different logics achieve the same goal. Molecular and Biochemical Parasitology, 134(1), 27-35.
- ALLRED, D.R., 1995. Immune evasion by Babesia bovis and Plasmodium falciparum: Cliff-dwellers of the parasite world. Parasitology Today, 11, 100–105.
- ALLSOPP, M.T.E.P., CAVALIER-SMITH, T., DE WAAL, D.T. & ALLSOPP, B.A., 1994. Phylogeny and evolution of the piroplasms. Parasitology, 108, 147–152.
- ANGUS, B. M., 1998. Tick Fever and the Cattle Tick in Australia. Brisbane, University of Queensland. PhD, 540.
- ANON., 1984. Tick and tick-borne disease control. A practical field manual. Tick-borne disease control. Rome: Food and Agricultural Organization of the United Nations, 2.
- ANON., 1998. Babesiosis. Onderstepoort Veterinary Research Institute, Agricultural Research Council, South Africa, 1–8.
- BARKER, S. C. & MURRELL. A., 2004. Systematics and evolution of ticks with a list of valid genus and species names. Parasitology Supplement, 129, S15-S36.
- BENITEZ, M.T., MONTENEGRO-JAMES, S., RAMOS, P., APONTE, J., OBREGON, J.M. & ARENAS, E.L., 1996. Production semi-industrial de vacuna anti-babesiosis origen cultivo in vitro. Veterinaria Tropical, 21, 59–74.
- BESSENGER, R. & SCHOEMAN, J.H., 1983. Serological response of cattle to infection with Babesia bigemina and Babesia bovis in southern Africa. Onderstepoort Journal of Veterinary Research, 50, 115–117.
- BIGALKE, R.D., 1976. Thoughts on the future control of ticks and tick-borne diseases in cattle in South Africa. Journal of the South African Biological Society, 17, 7–17.
- BOCK, R. E., 1999. Tick fever in the northern beef industry: prevalence, cost/benefit of vaccination, considerations for genotypes, livestock management and live cattle export. Sydney, Meat and Livestock Australia.
- BOCK, R. E. & DE VOS, A.J., 2001. Immunity following use of Australian tick fever vaccine: a review of the evidence. Australian Veterinary Journal, 79 (12), 832-839.
- BOCK, R. E., JACKSON, L., DE VOS, A. & JORGENSEN, W., 2004. Babesiosis of cattle. Parasitology, 129, S247-S269.
- BOCK, R. E., DE VOS, A.J. & MOLLOY, J.B., 2006. Tick-borne diseases of cattle. Australian New Zealand Standard Diagnostic Procedures. FARAGHER, J.T., Subcommittee on Animal Health Laboratory Standards.
- BOCK, R.E., 1999. Tick Fever Research Centre, Wacol, Queensland, Australia. Unpublished data.
- BOCK, R.E., DE VOS, A.J, KINGSTON, T.G. & MCLELLAN, D.J., 1997. Effect of breed of cattle on innate resistance to infection with Babesia bovis, Babesia bigemina and Anaplasma marginale. Australian Veterinary Journal, 75, 2–5.
- BOCK, R.E., DE VOS, A.J., LEW, A., KINGSTON, T.G. & FRASER, I.R., 1995. Studies on failure of T strain live Babesia bovis vaccine. Australian Veterinary Journal, 72, 296–300.
- BOCK, R.E., KINGSTON, T.G. & DE VOS, A.J., 1999. Effect of breed of cattle on transmission rate and innate resistance to infection with Babesia bovis and Babesia bigemina transmitted by Boophilus microplus. Australian Veterinary Journal, 77, 461–464.
- BOCK, R.E., KINGSTON, T.G., STANDFAST, N.F. & DE VOS, A.J., 1999. Effect of cattle breed on innate resistance to inoculation of Babesia bigemina. Australian Veterinary Journal, 77, 465–466.
- BOCK, R.E., LEW, A.E., MINCHIN, C.M., JESTON, P.J. & JORGENSEN, W.K., 2000. Application of PCR assays to determine the genotype of Babesia bovis parasites isolated from cattle with clinical babesiosissoon after vaccination against tick fever. Australian Veterinary Journal, 78, 179– 181.
- BÖSE, R., JORGENSEN, W.K., DALGLIESH, R.J., FRIEDHOFF, K.T. & DE VOS, A.J., 1995. Current state and future trends in the diagnosis of babesiosis. Veterinary Parasitology, 57, 61–74.
- BRIZUELA, C.M., ORTELLADO, C.A., SANABRIA, E., TORRES. O. & ORTIGOSA, D., 1998. The safety and efficacy of Australian tick-borne disease vaccine strains in cattle in Paraguay. Veterinary Parasitology, 76, 27–41.
- BROWN, W. C., NORIMINE, J., KNOWLES, D.P., GOFF, W.L., 2006. Immune control of Babesia bovis infection. Veterinary Parasitology, 138(1-2), 75-87.
- BROWN, W. C., NORIMINE, J., GOFF, W.L., SUAREZ, C.E. & MCELWAIN, T.F., 2006. Prospects for recombinant vaccines against Babesia bovis and related parasites. Parasite Immunology, 28(7), 315-327.
- BROWN, W.C. & LOGAN, K.S., 1992. Babesia bovis: bovine helper T cell lines reactive with soluble and membrane antigens of merozoites. Experimental Parasitology, 74, 188–199.
- BROWN, W.C. & RICE-FICHT, A.C., 1994. Use of helper T cells to identify potential vaccine antigens of Babesia bovis. Parasitology Today, 10, 145–149.
- BROWN, W.C., ESTES, D.M., CHANTLER, S.E., KEGERREIS, K.A. & SUAREZ, C.E., 1998. DNA and a CpG oligonucleotide derived from Babesia bovis are mitogenic for bovine B cells. Infection and Immunity, 66, 5423–5432.
- BROWN, W.C., MCELWAIN, T.F., HOTZEL, I., RUEF, B.J., RICE-FICHT, A.C., STICH, R.W., SUAREZ, C.E., ESTES, D.M. & PALMER, G.H., 1998. Immunodominant T-cell antigens and epitopes of Babesia bovis and Babesia bigemina. Annals of Tropical Medicine and Parasitology, 92, 473–482.
- BROWN, W.C., WOODS, V.M., DOBBELAERE, D.A.E. & LOGAN, K.S., 1993. Heterogeneity in cytokine profiles of Babesia bovis-specific bovine CD4+ T-cell clones activated in vitro. Infection and Immunity, 61, 3273–3281.
- BUSCHER, G., 1988. The infection of various tick species with Babesia bigemina, its transmission and identification. Parasitology Research, 74, 324–330.
- CALDER, J.A.M., REDDY, G.R., CHIEVES, L., COURTNEY, C.H., LITTELL R., LIVENGOOD, J.R., NORVAL, R.A.I., SMITH, C. & DAME, J.B., 1996. Monitoring Babesia bovis infections in cattle by using PCR-based tests. Journal of Clinical Microbiology, 34, 2748–2755.
- CALLOW, L. L. AND R. J. DALGLIESH (1982). Immunity and immunopathology in babesiosis. Immunology of parasitic infections. S. COHEN AND K. S. WARREN. Oxford, UK, Blackwell Scientific Publications Ltd, 475-526.
- CALLOW, L.L. & STEWART, N.P., 1978. Immunosuppression by Babesia bovis against its tick vector, Boophilus microplus. Nature (London), 272, 818–819.
- CALLOW, L.L., 1984. Animal Health in Australia. Protozoal and Rickettsial Diseases. Canberra: Australian Bureau of Animal Health, Australian Government Publishing Service, 5.
- CALLOW, L.L., KANHAI, G.K. & VANDENBERGHE, E., 1981. Serological comparison of strains of Babesia bovis occurring in Australia and Mozambique. Tropical Animal Health and Production, 13, 79–82.
- CALLOW, L.L., MCGREGOR, W., PARKER, R.J. & DALGLIESH, R.J., 1974. The immunity of cattle to Babesia argentina after drug sterilization of infections of varying duration. Australian Veterinary Journal, 50, 6–11.
- CALLOW, L.L., ROGERS, R.J. & DE VOS, A.J., 1993. Tick-borne Diseases: Cattle-Pathology and Serology. In: CORNER, L.A. & BAGUST, T.J., (eds). Australian Standard Diagnostic Techniques for Animal Diseases. CSIRO Information Services, East Melbourne, 1–16.
- CARTER, P., 2011. Innate susceptibility of various cattle breeds to tick fever caused by Babesia bovis and Anaplasma marginale. Sydney, Australia, Meat and Livestock Australia, North Sydney.
- CHUNGWON, J.C., SUAREZ, C.E., BANDARANAYAKE-MUDIYA, N.L., BANDARANAYAKE-MUDIYA, N., RZEPKA, J., HEINIGER, T.J., CHUNG, G., LEE, S.S., ADANS, E. & YUN, G., 2017. A novel modified-indirect ELISA based on spherical body protein 4 for detecting antibody during acute and long-term infections with diverse Babesia bovis strains. Parasites and Vectors, 10(1).
- CLARK, I.A., 1982. Correlation between susceptibility to malaria and babesia parasites and to endotoxicity. Transactions of the Royal Society of Tropical Medicine and Hygiene, 76, 4–7.
- CLARK, I.A., HUNT, N.H. & COWDEN, W.B., 1986. Oxygen-derived free radicals in the pathogenesis of parasitic disease. Advances in Parasitology, 25, 1–44.
- COOKE, B.M. & COPPEL, R.L, 1995. Cytoadhesion and Falciparum Malaria: Going with the flow. Parasitology Today, 11, 282–287.
- DALGLIESH, R.J. & STEWART, N.P., 1977. Tolerance to imidocarb induced experimentally in tick-transmitted Babesia argentina. Australian Veterinary Journal, 53, 176–180.
- DALGLIESH, R.J., 1993. Babesiosis. In: WARREN, K.S. (ed.). Immunology and Molecular Biology of Parasitic Infections. Oxford, UK: Blackwell, 352–383.
- DALGLIESH, R.J., CALLOW, L.L., MELLORS, L.T. & MCGREGOR, W., 1981. Development of a highly infective Babesia bigemina vaccine of reduced virulence. Australian Veterinary Journal, 57, 8–11.
- DALGLIESH, R.J., MOLLOY, J.B., BOCK, R.E. & JORGENSEN, W.K., 1995. Do parasite antigens on erythrocytes determine host-parasite relationships in Babesia infections in cattle? Lessons from Malaria. In: COONS, L. & ROTHCHILD, M., (eds). Proceedings of the 2nd International Conference on Tick-borne Pathogens at the Host-vector Interface: A Global perspective. United Litho.
- DALGLIESH, R.J., STEWART, N.P. & CALLOW, L.L., 1978. Transmission of Babesia bigemina by transfer of adult maleBoophilus microplus. Australian Veterinary Journal 54, 205–206.
- DALRYMPLE, B.P., JORGENSEN, W.K., DE VOS, A.J. & WRIGHT, I.G., 1992. Analysis of the composition of samples of Babesia bovis and the influence of different environmental conditions on genetically distinct subpopulations. International Journal for Parasitology, 22, 731–737.
- DE CLERCQ, E. M., LETA, S., ESTRADA-PEÑA, A., MADDER, M., ADEHAN, S. & VANWAMBEKE, S.O., 2015. Species distribution modelling for Rhipicephalus microplus (Acari: Ixodidae) in Benin, West Africa: Comparing datasets and modelling algorithms. Preventive Veterinary Medicine, 118(1), 8-21.
- DE ECHAIDE, S.T., ECHAIDE, I.E., GAIDO, A.B., MANGOLD, A.J., LUGARESI, C.I., VANZINI, V.R. & GUGLIELMONE, A.A., 1995. Evaluation of an enzyme-linked immunosorbent assay kit to detect Babesia bovis antibodies in cattle. Preventive Veterinary Medicine, 24, 277–283.
- DE VOS, A. J., IMES, G.D. & CULLEN, J.S.C., 1976. Cerebral babesiosis in a new-born calf. Onderstepoort Journal of Veterinary Research, 43(2), 75-78.
- DE VOS, A.J. & JORGENSEN, W.K., 1992. Protection of cattle against babesiosis in tropical and subtropical countries with a live, frozen vaccine. In: FIVAZ, B.H., PETNEY, T.N & HORAK, I.G. (eds). Tick Vector Biology, Medical and Veterinary Aspects. Berlin: Springer Verlag, 159–174.
- DE VOS, A.J. & POTGIETER, F.T., 1983. The effect of tick control on the epidemiology of bovine babesiosis. Onderstepoort Journal of Veterinary Research, 50, 3–5.
- DE VOS, A.J., 1979. Epidemiology and control of bovine babesiosis in South Africa. Journal of the South African Veterinary Association, 50, 357–362.
- DE VOS, A.J., BESSENGER, R. & FOURIE, C.G., 1982. Virulence and heterologous strain immunity of South African and Australian Babesia bovis strains with reduced pathogenicity. Onderstepoort Journal of Veterinary Research, 49, 133–136.
- DE VOS, A.J., COMBRINK, M.P. & BESSENGER, R., 1982. Babesia bigemina vaccine: Comparison of the efficacy and safety of Australian and South African strains under experimental conditions in South Africa. Onderstepoort Journal of Veterinary Research, 49, 155–158.
- DE VOS, A.J., DALGLIESH, R.J. & CALLOW, L.L., 1987. Babesia. In: SOULSBY, E.J.L., (ed.). Immune Responses in Parasitic Infections: Immunology, Immunopathology and Immunoprophylaxis. Protozoa. Boca Raton, Florida: CRC Press, Inc, 111.
- DE VOS, A.J., DALGLIESH, R.J. & MCGREGOR, W., 1986. Effect of imidocarb dipropionate prophylaxis on the infectivity and immunogenicity of a Babesia bovis vaccine in cattle. Australian Veterinary Journal, 63, 174–177.
- DE VOS, A.J., JORGENSEN, W.K. & MOLLOY, J.B., 2000. Bovine babesiosis, In: Manual of Standards for Diagnostic Tests and Vaccines. Third Edition, Office International des Epizootie, in press.
- DE WAAL, D. T. & COMBRINK, M.P., 2006. Live vaccines against bovine babesiosis. Veterinary Parasitology, 138(1-2), 88-96.
- DE WAAL, D.T., 1989. Veterinary Research Institute, Onderstepoort, South Africa. Unpublished data.
- DE WAAL, D.T., 1996. Vaccination against babesiosis. In: Proceedings of the VIII International Congress of Parasitology. Acta Parasitologica Turcica, 20, 487–499. Supplement. 1
- DE WAAL, D.T., POTGIETER, F.T., COMBRINK, M.P. & MASON, T. E., 1990. The isolation and transmission of an unidentified Babesia spp. to cattle by Hyalomma truncatum Koch 1844. Onderstepoort Journal of Veterinary Research, 57, 229–232.
- DU PLESSIS, J.L., DE WAAL, D.T. & STOLTSZ, W.H., 1994. A survey of the incidence and importance of the tick-borne diseases heartwater, redwater and anaplasmosis in the heartwater-endemic regions of South Africa. Onderstepoort Journal of Veterinary Research, 61, 295–301.
- EHRET, W.J. POTGIETER, F.T., DE WAAL, D.T., VAN DER LUGT, J.J. & VAN DER VYVER, F.H., 1987. Chronic splenitis as a possible complicating factor in calves inoculated with an attenuated redwater vaccine. Journal of the South African Veterinary Association, 58, 131–134.
- EL-GAYSH, A., SUNDQUIST, B., CHRISTENSSON, D.A., HILALI, M. & NASSER, A.M., 1996. Observations on the use of ELISA for detection of Babesia bigemina specific antibodies. Veterinary Parasitology, 62, 51–61.
- ELLISSALDE, G.S., WAGNER, G.G., CRAIG, T.M., ELLISSALDE, M.H & ROWEL., 1983. Hypocholesterolemia and hypocortisolemia in acute and terminal Babesia bovis infections. Veterinary Parasitology, 12, 1–11.
- EMERY, D.L. 1981. Adoptive transfer of immunity to infection with Theileria parva (East Coast Fever) between cattle twins. Research in Veterinary Science, 30, 364–367.
- ENTWISTLE, K., 1992. Effects of heat stress on reproductive function of bulls. In: HOLROYD, R.G. (ed.). Bull Fertility. Conference and Workshop series QC93008, Department of Primary Industries, Queensland, Australia.
- ESTRADA-PEÑA, A., BOUATTOUR, A., CAMICAS, J.L., GUGLIELMONE, A., HORAK, I., JONGEJAN, F., LATIF, A., PEGRAM, R. & WALKER, A., 2006. The known distribution and ecological preferences of the tick subgenus Boophilus (Acari: Ixodidae) in Africa and Latin America. Experimental and Applied Acarology, 38(2-3), 219-235.
- FIGUEROA, J.V., CHIEVES, L.P., JOHNSON, G.S. & BUENING, G.M., 1992. Detection of Babesia bigemina-infected carriers by polymerase chain reaction amplification. Journal of Clinical Microbiology, 30, 2576–2582.
- FLORIN-CHRISTENSEN, M., SUAREZ, C.E., RODRIGUEZ, A.E., FLORES, D.A. & SCHNITTGER, L., 2014. Vaccines against bovine babesiosis: where we are now and possible roads ahead. Parasitology, 141(12), 1563-1592.
- FRIEDHOFF, K. & BÖSE, R., 1994. Recent developments in diagnostics of some tick-borne diseases. In: UILENBERG, G., PERMIN, A. & HANSEN, J.W., (eds). Use of applicable biotechnological methods for diagnosing haemoparasites. Proceedings of the Expert Consultation, Merida, Mexico, 4–6 October 1993, FAO, Rome, Italy, 46–57.
- FRIEDHOFF, K.F., 1988. Transmission of Babesia. In: RISTIC, M., (ed.). Babesiosis of Domestic Animals and Man. Boca Raton, Florida: CRC Press, Inc.
- GALE, K.R., WALTISBUHL, D.J., BOWDEN, J.M., JORGENSEN, W.K., MATHESON, J., EAST, I.J., ZAKRZEWSKI, H. & LEATCH, G., 1998. Amelioration of virulent Babesia bovis infection in calves by administration of the nitric oxide synthase inhibitor aminoguanidine. Parasite Immunology, 20, 441–445.
- GILL, A.C., COWMAN, A.F., STEWART, N.P., KEMP, D.J. & TIMMS, P., 1987. Babesia bovis: Molecular and biological characteristics of cloned parasite lines. Experimental Parasitology, 63, 180–188.
- GOFF, W. L., MALLOY, J.B., JOHNSON, W.C., SUAREZ, C.E., PINO, I., RHALEM, A., SAHIBI., CECI, L., CARELLI, G. & SCOTT ADAMS, D., MCGUIRE, T.C., KNOWLES, D.P. & MCELWAIN, T.F., 2006. Validation of a competitive enzyme-linked immunosorbent assay for detection of antibodies against Babesia bovis. Clinical and Vaccine Immunology, 13(11), 1212-1216.
- GOFF, W. L., JOHNSON, W.C., MOLLOY, J.B., JORGENSEN, W.K., WALDRON, S.J., FIGUEROA, J.V., MATTHEE, O., SCOTT ADAMS, D., MCGUIRE, T.C., PINO, I., MOSQUEDA, J., PALMER, G.H., SUAREZ, C.E., KNOWLES, D.P., MCELWAIN, T.F., 2008. Validation of a competitive enzyme-linked immunosorbent assay for detection of Babesia bigemina antibodies in cattle. Clinical and Vaccine Immunology, 15(9), 1316-1321.
- GOFF, W. L., BASTOS, R.G., BROWN, W.C., JOHNSON, W.C. & SCHNEIDER, D.A., 2010. The bovine spleen: Interactions among splenic cell populations in the innate immunologic control of hemoparasitic infections. Veterinary Immunology and Immunopathology, 138(1-2), 1-14.
- GOFF, W.L. & WAGNER, G.G., 1982. The bovine immune response to tick-derived Babesia bovis infection: serological studies of isolated immunoglobulins. Veterinary Parasitology, 11, 109–120.
- GOFF, W.L. & WAGNER, G.G., 1984. The role of specific immunoglobulins in antibody-dependent cell-mediated cytotoxicity assays during Babesia bovis infection. Veterinary Parasitology, 14, 117–128.
- GOHIL, S., KATS, L.M., STURM, A. & COOKE, B.M., 2010. Recent insights into alteration of red blood cells by Babesia bovis: moovin' forward. Trends in Parasitology, 26(12), 591-599.
- GOODGER, B.V., RODE-BRAMANIS, K. & WRIGHT, I.G., 1987. Procoagulant activity of Babesia bovis-infected erythrocytes. Journal of Parasitology, 73, 1052–1053.
- GOODGER, B.V., WRIGHT, I.G., MAHONEY, D.F. & MCKENNA, R.V., 1980. Babesia bovis (argentina): Studies on the composition and location of antigen associated with infected erythrocytes. International Journal for Parasitology, 10, 33–36.
- GRAY, J.S. & DE VOS, A.J., 1981. Studies on a bovine Babesia transmitted by Hyalomma marginatum rufipes Koch, 1844. Onderstepoort Journal of Veterinary Research, 48, 215–223.
- GRAY, J.S. & POTGIETER, F.T., 1981. The retention of Babesia bigemina infection by Boophilus decoloratus exposed to imidocarb dipropionate during engorgement. Onderstepoort Journal of Veterinary Research, 48, 225–227.
- HE, L., LIU, Q., YAO, B., ZHOU, Y., HU, M., FANG, R. & ZHAO, J., 2017. A historical overview of research on Babesia orientalis, a protozoan parasite infecting water buffalo. Frontiers in Microbiology, 8.
- HENNING, M.W., 1956.Animal Diseases in South Africa. 3rd edition. Pretoria: Central News Agency Ltd.
- HOLMAN, P.J., FRERICHS, W.M., CHIEVES, L. & WAGNER, G.G., 1993. Culture confirmation of carrier status of Babesia caballi-infected horses. Journal of Clinical Microbiology, 31, 698–701.
- HORAK, I. G., NYANGIWE, N., DE MATOS, C. & NEVES, L., 2009. Species composition and geographic distribution of ticks infesting cattle, goats and dogs in a temperate and in a subtropical region of south-east Africa. Onderstepoort Journal of Veterinary Research, 76(3), 263-276.
- HOVE, T., SITHOLE, N., MUNODZANA, D. & MASAKA, S., 1998. Isolation and characterization of a Babesia species from Rhipicephalus evertsi evertsi ticks picked off a sable antelope (Hippotragus niger) which died of acute babesiosis. Onderstepoort Journal of Veterinary Research, 65, 75–80.
- HOWELL, C.J., WALKER, J.B. & NEVILL, E.M., 1978. Ticks, Mites and Insects of Domestic Animals in South Africa. Part 1: Description and Biology. Scientific pamphlet No. 393, Department of Agricultural Technical Services, Republic of South Africa.
- HOYTE, H.M.D., 1976. The tick-fever parasites of cattle. Proceedings of the Royal Society of Queensland, 87, v–viii. (http://www.agriculture.gov.au/animal/health/laboratories/procedures/anzsdp/tick-borne-diseases.)
- JOHNSON, W.C., CLUFF, C.W., GOFF, W.L. & WYATT, C.R., 1996. Reactive oxygen and nitrogen intermediates and products from polyamine degradation are babesiacidal in vitro. Annals of the New York Academy of Sciences, 791, 136–147.
- JOHNSTON, L.A.Y., LEATCH, G. & JONES, P.N., 1978. The duration of latent infection and functional immunity of Droughtmaster and Hereford cattle following natural infection with Babesia argentina and Babesia bigemina. Australian Veterinary Journal, 54, 14–18.
- JOHNSTON, L.A.Y., TRUEMAN, K.F. & PEARSON, R.D., 1977. Bovine babesiosis: Comparison of fluorescent antibody and Giemsa staining in post mortem diagnosis of infection. Australian Veterinary Journal, 53, 222–226.
- JONGEJAN, F., PERRY, B.D., MOORHOUSE, P.D.S., MUSISI, F.L., PEGRAM, R.G. & SNACKEN, M., 1988. Epidemiology of bovine babesiosis and anaplasmosis in Zambia. Tropical Animal Health and Production, 20, 234–242.
- JORGENSEN, W.K., BOCK, R.E., KINGSTON, T.G., DE VOS, A.J. & WALDRON, S.J., 1993. Assessment of tetracycline and Babesia culture supernatant as prophylactics for moderating reactions in cattle to live Babesia and Anaplasma vaccines. Australian Veterinary Journal, 70, 35–36.
- JORGENSEN, W.K., DE VOS, A.J. & DALGLIESH, R.J., 1989. Infectivity of cryopreserved Babesia bovis, Babesia bigemina and Anaplasma centrale for cattle after thawing, dilution and incubation at 30 °C. Veterinary Parasitology, 3, 243–251.
- JORGENSEN, W.K., WALDRON, S.J., MCGRATH, J., ROMAN, R.J., DE VOS, A.J. & WILLIAMS, K.E., 1992. Growth of Babesia bigemina parasites in suspension cultures for vaccine production. Parasitology Research, 78, 423–426.
- JOYNER, L.P. & DONNELLY, J., 1979. The epidemiology of babesial infections. Advances in Parasitology, 17, 115–140.
- KATSANDE, T.C. & TURTON, J.A., 1995. Progress on the production of frozen Anaplasma and Babesia whole blood vaccines at Central Veterinary Laboratory, Harare. Zimbabwe Veterinary Association Congress, Juliasdale, 11–15 September 1995.
- KELLERMAN, T.S., COETZER, J.A.W. & NAUDE, T.W., 1988. Plant Poisonings and Mycotoxicoses of Livestock in Southern Africa. Cape Town: Oxford University Press Southern Africa.
- KUMAR, S., GOOD, M.F., DONTFRAID, F., VINETZ, J.M. & MILLER, L.H., 1989. Interdependence of CD4+ T cells and malarial spleen in immunity to Plasmodium vinckei vinckei. Journal of Immunology, 143, 2017–2023.
- KUNG’U, M. W. & GOODGER, B.V., 1990. A slide enzyme-linked assay (SELISA) for the diagnosis of Babesia bovis infections and for the screening of Babesia-specific monoclonal antibodies. International Journal for Parasitology, 20, 341–345.
- KUTTLER, K.L. & ALIU, Y.O., 1984. Chemotherapy of babesiosis. In: RISTIC, M., AMBROSE-THOMAS, P. & KREIER, J., (eds). Malaria and Babesiosis. Dordrecht: Martinus Nijhof Publishers.
- KUTTLER, K.L., 1988. Chemotherapy of babesiosis. In: RISTIC, M. (ed). Babesiosis of Domestic Animals and Man. Boca Raton, Florida: CRC Press Inc. New York.
- LAU, A. O. T., KALYANARAMAN, A., ECHAIDE, I., PALMER, G.H., BOCK, R., PEDRONI, M.J., RAMESHKUMAR, M., FERREIRA, M.B., FLETCHER, T.I. & MCELWAIN, T.F., 2011. Attenuation of virulence in an apicomplexan hemoparasite results in reduced genome diversity at the population level. BMC Genomics, 12.
- LAWRENCE, J.A. & NORVAL, R.A.I., 1979. A history of ticks and tick-borne diseases of cattle in Rhodesia. Rhodesian Veterinary Journal, 10, 28–40.
- LAWRENCE, J.A., FOGGIN, C.M. & NORVAL, R.A.I., 1980. The effects of war on the control of diseases in livestock in Rhodesia (Zimbabwe). The Veterinary Record, 107, 82–85.
- LEVINE, N.D., 1971. Taxonomy of the piroplasms. Transactions of the American Microscopical Society, 90, 2–33.
- LEVINE, N.D., 1985. Veterinary Protozoology. Ames, Iowa: Iowa State University Press.
- LEW, A., DALRYMPLE, B.P., JESTON, P.J. & BOCK. R.E., 1997. PCR methods for the discrimination of Babesia bovis isolates. Veterinary Parasitology, 71, 223-237.
- LIU, J., GUAN, G., LIU, A., LI, Y., YIN, H. & LUO, J., 2008. Discrimination of Babesia major and Babesia ovata based on ITS1-5.8S-ITS2 region sequences of rRNA gene. Parasitology Research, 102(4), 709-713.
- LOHR, K.F., 1972. Immunity of Babesia bigemina in experimentally infected cattle. Journal of Protozoology, 19, 658–660.
- LOHR, K.F., 1973. Susceptibility of non-splenectomized and splenectomized Sahiwal cattle to experimental Babesia bigemina infection. Zentralblatt fu¨r Veterinarmedizin, 20, 52–56.
- LORUSSO, V., WIJNVELD, M., MAJEKODUNMI, A.O., DONGKUM, C., FAJINMI, A., DOGO, A.G., THRUSFIELD, M., MUGENYI, A., VAUMOURIN, E., IGWEL, A.C., JONGEJAN, F., WELBURN, S.C. & PICOZZI, K., 2016. Tick-borne pathogens of zoonotic and veterinary importance in Nigerian cattle. Parasites and Vectors, 9(1).
- MAHONEY, D.F. & MIRRE, G.B., 1971. Bovine babesiosis: Estimation of infection rates in the tick vector Boophilus microplus (Canestrini). Annals of Tropical Medicine and Parasitology, 65, 309–317.
- MAHONEY, D.F. & ROSS, D.R., 1972. Epizootiological factors in the control of bovine babesiosis. Australian Veterinary Journal, 48, 292–298.
- MAHONEY, D.F., 1969. Bovine babesiosis: A study of factors concerned in transmission. Annals of Tropical Medicine and Parasitology, 63, 1–14.
- MAHONEY, D.F., 1972. Immune response to haemoprotozoa. Babesia spp.. In: SOULSBY, E.J.L., (ed.). Immunity to Animal Parasites. New York: Academic Press, 11.
- MAHONEY, D.F., WRIGHT, I.G. & GOODGER, B.V., 1979. Immunity in cattle to Babesia bovis after single infections with parasites of various origin. Australian Veterinary Journal, 55, 10–12.
- MAHONEY, D.F., WRIGHT, I.G. & MIRRE, G.B., 1973. Bovine babesiosis: The persistence of immunity to Babesia argentine and Babesia bigemina in calves (Bos taurus) after naturally acquired infection. Annals of Tropical Medicine and Parasitology, 67, 197–203.
- MAHONEY, D.F., WRIGHT, I.G., GOODGER, B.V., MIRRE, C.B., SUTHERST, R.W. & UTECH, K.B.W., 1981. The transmission of Babesia bovis in herds of European and Zebu x European cattle infested with the tick, Boophilus microplus. Australian Veterinary Journal, 57, 461–469.
- MANGOLD, A.J., VANZINI, V.R., ECHAIDE, I.E., DE ESCHAIDE, S.T., VOLPOGNI, M.M. & GUGLIELMONE, A.A., 1996. Viability after thawing and dilution of simultaneously cryopreserved vaccinal Babesia bovis and Babesia bigemina strains cultured in vitro. Veterinary Parasitology, 61, 345–348.
- MASON, C.A. & NORVAL, R.A.I., 1981. The transfer of Boophilus microplus (Acarina: Ixodidae) from infested to uninfested cattle under field conditions. Veterinary Parasitology, 8, 185–188.
- MASON, T.E., POTGIETER, F.T. & VAN RENSBURG, L., 1986. The inability of a South African Babesia bovis vaccine strain to infect Boophilus microplus. Onderstepoort Journal of Veterinary Research, 53, 143–145.
- MCCOSKER, P.J., 1981. The global importance of babesiosis. In: RISTIC, M. & KREIER, J.P., (eds). Babesiosis. New York: Academic Press.
- MECKENSTEDT, U., GAUER, M., FUCHS, P., ZAPF, F., SCHEIN, E. & MEHLHORN, H., 1995. DNA measurements reveal differences in the life cycles of Babesia bigemina and Babesia canis, two typical members of the genus Babesia. Parasitology Research, 81, 595–604.
- MEHLITZ, D. & EHRET, R., 1974. Serological investigations on the prevalence of anaplasmosis and piroplasmosis in cattle in Botswana. Tropenmedizin und Parasitologie, 25, 3–10.
- MOLLOY, J. B., ET AL., 1998. Evaluation of an ELISA for detection of antibodies to Babesia bovis in cattle in Australia and Zimbabwe. Preventive Veterinary Medicine, 33(1-4), 59-67.
- MOLLOY, J.B., BOWLES, P.M., BOCK, R.E., TURTON, J.A., KATSANDE, T.C., KATENDE, J.M., MABIKACHECHE, L.G., WALDRON, S.J., BLIGHT, G.W. & DALGLIESH, R.J., 1998. Evaluation of an ELISA for detection of antibodies to Babesia bovis in cattle in Australia and Zimbabwe. Preventive Veterinary Medicine, 33, 59–67.
- MOLLOY, J.B., BOWLES, P.M., JESTON, P.J., BRUYERES, A.G., BOWDEN, J.M., BOCK, R.E., JORGENSEN, W.K., BLIGHT, G.W. & DALGLIESH, R.J., 1998. Development of an enzyme-linked immunosorbent assay for detection of antibodies to Babesia bigemina in cattle. Parasitology Research, 84, 651–656.
- MONTEALEGRE, F., LEVY, M.G., RISTIC, M. & JAMES, M.A., 1985. Growth inhibition of Babesia bovis in culture by secretions from bovine mononuclear phagocytes. Infection and Immunity, 50, 523–526.
- MONTENEGRO-JAMES, S., TORO, M., LEON, E., GUILLEN, A.T., LOPEZ, R. & LOPEZ, W., 1992. Immunisation of cattle with an inactivated polyvalent vaccine against anaplasmosis and babesiosis. Annals of the New York Academy of Science, 653, 112–121.
- MOSQUEDA, J., OLVERA-RAMIREZ, A., AGUILAR-TIPACAMU, G. & CANTO, G.J., 2012. Current Advances in Detection and Treatment of Babesiosis. Current Medicinal Chemistry, 19(10), 1504-1518.
- MUSOKE, A.J., PALMER, G.H., MCELWAIN, T.F., NENE, V. & MCKEEVER D., 1996. Prospects for subunit vaccines against tick-borne diseases. British Veterinary Journal, 152, 621–639.
- NEITZ, W.O., 1941. The occurrence of Babesia bovis in South Africa. Journal of the South African Veterinary Medical Association, 12, 62–66.
- NEITZ, W.O., 1969. Observations on the duration of premunity following administration of the bivalent redwater vaccine. Journal of the South African Veterinary Medical Association, 40, 419–420.
- NORVAL, R.A.I., 1979. Tick infestations and tick-borne diseases in Zimbabwe Rhodesia. Journal of the South African Veterinary Association, 50, 289–292.
- NORVAL, R.A.I., FIVAZ, B.H., LAWRENCE, J.A. & DAILLECOURT, T., 1983. Epidemiology of tick-borne diseases of cattle in Zimbabwe. 1. Babesiosis. Tropical Animal Health and Production, 15, 87–94.
- OIE (World Organisation for Animal Health)., 2017. Bovine babesiosis. Manual of Diagnostic Tests and Vaccines for Terrestrial Animals. 1. (http://www.oie.int/international-standard-setting/terrestrial-manual/access-online/.)
- PALMER, G.H. & MCELWAIN, T.F., 1995. Molecular basis for vaccine development against anaplasmosis and babesiosis. Veterinary Parasitology, 57, 233–253.
- PERRY, B.D., 1996. Epidemiological indicators and their application to the control of tick-borne diseases. In: Manual on Tick and Tick-borne Disease Control. Food and Agricultural Organisation, Rome.
- PERRY, B.D., MUSISI, F.L., PEGRAM, R.G. & SCHELS, E.L.F., 1985. Assessment of endemic stability to tick-borne diseases. World Animal Review, 56, 24–32.
- PIENAAR, L., GROBLER, J.P., SCHOLTZ, M.M., SWART, H., EHLERS, M., MARX, M.P., MACNEIL, M.D. & NESER, F.W.C., 2017. Genetic diversity of Afrikaner cattle in southern Africa. Tropical Animal Health and Production, 1-6.
- PIPANO, E., 1981. Frozen vaccines against tick fevers of cattle. In: MEYER, E., (ed.). Eleventh International Congress on Diseases of Cattle. Haifa, Israel: Bregman Press.
- PIPANO, E., 1995. Live vaccines against hemoparasitic diseases of livestock. Veterinary Parasitology, 57, 213–231.
- POTGIETER, F.T. & ELS, H.J., 1976. Light and electron microscopic observations on the development of small merozoites of Babesia bovis in Boophilus microplus larvae. Onderstepoort Journal of Veterinary Research, 43, 123–128.
- POTGIETER, F.T. & ELS, H.J., 1977. Light and electron microscopic observations on the development of Babesia bigemina in larvae, nymphae and non-replete females ofBoophilus decoloratus. Onderstepoort Journal of Veterinary Research, 44, 213–232.
- POTGIETER, F.T. & ELS, H.J., 1977. The fine structure of intra-erythrocytic stages of Babesia bigemina. Onderstepoort Journal of Veterinary Research, 44, 157–168.
- POTGIETER, F.T. & ELS, H.J., 1979. An electron microscopic study of intra-erythrocytic stages of Babesia bovis in the brain capillaries of infected splenectomized calves. Onderstepoort Journal of Veterinary Research, 46, 41–49.
- POTGIETER, F.T. & VAN VUUREN, A.S., 1974. The transmission of Babesia bovis using frozen infective material obtained from Boophilus microplus larvae. Onderstepoort Journal of Veterinary Research, 41, 79–80.
- POTGIETER, F.T., 1977. The life cycle of Babesia bovis and Babesia bigemina in ticks and in cattle in South Africa. Ph.D. Thesis, Rand Afrikaans University.
- PURNELL, R.E., BRANAGAN, D. & BROWN, C.G.D., 1970. Attempted transmission of some piroplasms by rhipicephalid ticks. Tropical Animal Health and Production, 2, 146–150.
- RAMSAY, G.C., 1997. Setting Animal Health Priorities: A veterinary and economic analysis with special reference to the control of Babesia bovis in central Queensland. PhD Thesis, University of Queensland.
- ROGERS, R.J., 1971. Observations of the pathology of Babesia argentina infections in cattle. Australian Veterinary Journal, 47, 242–247.
- ROGERS, R.J., DIMMOCK, C.K., DE VOS, A.J. & RODWELL, B.J., 1988. Bovine leucosis virus contamination of a vaccine produced in vivo against bovine babesiosis and anaplasmosis. Australian Veterinary Journal, 65, 285–287.
- SCHETTERS, T.P., KLEUSKENS, J., SCHOLTES, N., GORENFLOT, A., 1998. Parasite localization and dissemination in the Babesia-infected host. Annals of Tropical Medical Parasitology, 92, 513–518.
- SPICKETT, A.M. & MALAN, J.R., 1978. Genetic incompatibility between Boophilus decoloratus (Koch, 1844) and Boophilus microplus (Canestrini, 1888) and hybrid sterility of Australian and South African Boophilus microplus (Acarina: Ixodidae). Onderstepoort Journal of Veterinary Research, 45, 149–153.
- STANDFAST, N.F. & JORGENSEN, W.K., 1997. Comparison of the infectivity of Babesia bovis, Babesia bigemina and Anaplasma centrale for cattle after cryopreservation in either dimethylsulphoxide (DMSO) or polyvinylpyrolidone (PVP). Australian Veterinary Journal, 75, 62–63.
- STEWART, N.P., 1978. Differences in the life cycle between a vaccine strain and an unmodified strain of Babesia bovis (Babes, 1889) in the tick Boophilus microplus (Canestrini). Journal of Protozoology, 25, 497–501.
- STICH, R.W., SHODA, L.K., DREEWES, M., ADLER, B., JUNGI, T.W. & BROWN, W.C., 1998. Stimulation of nitric oxide production in macrophages by Babesia bovis. Infection and Immunity, 66, 4130–4136.
- SUTHERST, R.W., 1983. Management of arthropod parasitism in livestock. In: DUNSMORE, J.D., (ed.). Tropical Parasitoses and Parasitic Zoonoses. Perth: World Association for the Advancement of Veterinary Parasitology.
- SUTHERST, R.W., 1987. The dynamics of hybrid zones between tick (Acari) species. International Journal for Parasitology, 17, 921–926.
- TAYLOR, R.J. & MCHARDY, N., 1979. Preliminary observations on the combined use of imidocarb and Babesia blood vaccine in cattle. Journal of the South African Veterinary Association, 50, 326–329.
- THEILER, A., 1905. Redwater. Transvaal Agricultural Journal, 3, 476–496.
- THEILER, A., 1912. Gall-sickness of imported cattle, and the protective inoculation against this disease. Agricultural Journal, 3, 1–21.
- THEILER, G., 1975. Past workers on tick and tick-borne diseases in southern Africa. Journal of the South African Veterinary Association, 46, 1–8.
- TIMMS, P., DALGLIESH, R.J., BARRY, D.N., DIMMOCK, C.K. & RODWELL, B.J., 1983. Babesia bovis: comparison of culture-derived parasites, non-living antigen and conventional vaccine in the protection of cattle against heterologous challenge. Australian Veterinary Journal, 60, 75-77.
- TIMMS, P., STEWART, N.P. & DE VOS, A.J., 1990. Study of virulence and vector transmission of Babesia bovis by use of cloned parasite lines. Infection and Immunity, 58, 2171–2176.
- TIMMS, P., STEWART, N.P., RODWELL, B.J. & BARRY, D.N., 1984. Immune responses of cattle following vaccination with living and non-living Babesia bovis antigens. Veterinary Parasitology, 16, 243–251.
- TJORNEHOJ, K., LAWRENCE, J.A., KAFUWA, P.T., WHITELAND, A.P. & CHIMERA B.A.R., 1997. Immunisation of smallholder dairy cattle against anaplasmosis and babesiosis in Malawi. Tropical Animal Health and Production, 29, 77–82.
- TRUEMAN, K.F. & BLIGHT, G.W., 1978. The effects of age on resistance of cattle to Babesia bovis. Australian Veterinary Journal, 54, 301–305.
- UILENBERG, G., 2006. Babesia-A historical overview. Veterinary Parasitology, 138(1-2), 3-10.
- WALDRON, S. J. AND W. K. JORGENSEN., 1999. Transmission of Babesia spp. by the cattle tick (Boophilus microplus) to cattle treated with injectable or pour-on formulations of ivermectin and moxidectin. Australian Veterinary Journal, 77(10), 657-659.
- WALTISBUHL, D.J., GOODGER, B.V, WRIGHT, I.G., COMMINS, M.A. & MAHONEY, D.F., 1987. An enzyme linked immunosorbent assay to diagnose Babesia bovis infection in cattle. Parasitology Research, 73, 126–131.
- WOOLLATT, S.B., 1913. Bovine piroplasmosis. In: HOARE, E.W. (ed.). A System of Veterinary Medicine. Vol. 1. Microbial Diseases. London: Bailliere, Tindall & Cox.
- WRIGHT, I.G. & GOODGER, B.V., 1988. Pathogenesis of babesiosis. In: RISTIC, M., (ed). Babesiosis of Domestic Animals and Man. Boca Raton, Florida: CRC Press Inc. New York: Academic Press.
- WRIGHT, I.G., 1972. An electron microscopic study of intravascular agglutination in the cerebral cortex due to Babesia argentina infection. International Journal for Parasitology, 2, 209–215.
- WRIGHT, I.G., 1972. Studies on the pathogenesis of Babesia argentina and Babesia bigemina infections in splenectomised calves. Zeitschrift fu¨r Parasitenkunde, 39, 85–102.
- WRIGHT, I.G., 1979. The kallikrein-kinin system and its role in the hypotensive shock syndrome of animals infected with the haemoprotozoan parasites Babesia, Plasmodium and Trypanosoma. General Pharmacology, 10, 319–325.
- WRIGHT, I.G., 1981. Biochemical characteristics of Babesia and physicochemical reactions in the host. In: RISTIC, M. & KREIER, J.P., (eds). Babesiosis. New York: Academic Press.
- WRIGHT, I.G., CASU, R., COMMINS, M.A., DALRYMPLE, B.P., GALE, K.R., GOODGER, B.V., RIDDLES, P.W., WALTISBUHL, D.J., ABETZ, I., BERRIE, D.A. et al., 1992. The development of a recombinant Babesia vaccine. Veterinary Parasitology, 44, 3–13.
- WRIGHT, I.G., GOODGER, B.V. & CLARK, I.A., 1988. lmmunopathophysiology of Babesia bovis and Plasmodium falciparum infections. Parasitology Today, 4, 214–218.
- WRIGHT, I.G., GOODGER, B.V., LEATCH, G., AYLWARD, J.H., RODE-BRAMANIS, K. & WALTISBUHL, D.J., 1987. Protection of Babesia bigemina-immune animals against subsequent challenge with virulent Babesia bovis. Infection and Immunity, 55, 364–368.
- WRIGHT, I.G., GOODGER, B.V., MCKENNA, R.V. & MAHONEY, D.F., 1979. Acute Babesia bovis infection: A study of the vascular lesions in kidney and lung. Zeitschrift fu¨r Parasitenkunde, 60, 19–27.
- WRIGHT, I.G., WALTISBUHL, D.J., MAHONEY, D.F. & GOODGER, B.V., 1982. Acute Babesia bovis infections: Metabolic and blood gas changes during infection. British Veterinary Journal, 138, 61–69.
- YERUHAM, I., AVIDAK, Y., AROCH, I. & HADANI, A., 2003. Intra-uterine Infection with Babesia bovis in a 2-day-old Calf. Journal of veterinary medicine. B, Infectious diseases and veterinary public health, 50(2), 60-62.
- ZINTL, A., MULCHANY, G., SKERRETT, H.E., TAYLOR, S.M. & GRAY, J.S., 2003. Babesia divergens: A Bovine Blood Parasite of Veterinary and Zoonotic Importance. Clinical Microbiology Reviews, 16 622-636.
- ZWART, D. & BROCKLESBY, D.W., 1979. Babesiosis: Nonspecific resistance, immunological factors and pathogenesis. Advances in Parasitology, 17, 49–113.
- ZWEYGARTH, E., VAN NIEKERK, C., JUST, M.C. & DE WAAL, D.T., 1995. In: vitro cultivation of a Babesia spp. from cattle in South Africa. Onderstepoort Journal of Veterinary Research, 62, 139–142.